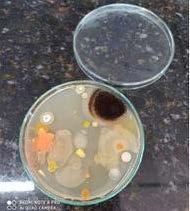
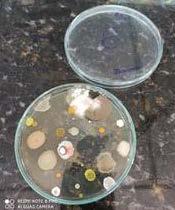

Oficina _Produção de mudas e manejo de espécies arbóreas_ da água e formas de tratamento simplificado




Oficina _Produção de mudas e manejo de espécies arbóreas_ da água e formas de tratamento simplificado



 Dona Helena
Dona Helena
AExtensão no IFNMG é concebida como uma instância fundamental para o aprimoramento e fortalecimento do processo educativo, cultural e científico e, ainda, como um componente que se articula ao Ensino e à Pesquisa de forma indissociável, buscando, assim, viabilizar uma relação dinâmica e transformadora entre o Instituto e a sociedade. Vale salientar que, nessa articulação, procura-se valorizar e estabelecer a troca de saberes sistematizados, acadêmicos e populares, fundamentada numa postura dialética da relação teoria/prática. A atuação da Extensão e sua dinamicidade em relação à articulação teoria/prática se configuram como espaço destinado ao acolhimento da diversidade de saberes e da sua plena expressão. Assim, a função primordial de todas as ações da Extensão se consolida no esforço de contribuir para a construção das práticas de Ensino, da Pesquisa e dos saberes de toda a comunidade. Pois, dessa forma, o reconhecimento da multiplicidade de saberes contribui, consequentemente, para o desenvolvimento local e regional, por meio de uma dinâmica interação entre a vida acadêmica e o contexto social. O IFNMG, ao assumir essas convicções, expressa, por meio de suas ações de Extensão, o reconhecimento de seu papel como articulador dos saberes do mundo, da vida e da instância acadêmica. Dessa forma, propõese a desconstruir a hegemonia que valida apenas uma forma de saber, possibilitando, assim, a desestabilização de um único conhecimento como detentor da verdade. Tal postura credencia a Extensão como um espaço privilegiado de produção de conhecimento e de compromisso com uma formação integral e cidadã, instaurada numa postura dialógica entre a instituição e a sociedade, consubstanciada no compromisso ético e humano.
 Dona Helena
Dona Helena
 A ponte, as garças e o majestoso Velho Chico
A ponte, as garças e o majestoso Velho Chico
I. desenvolver atividades de acordo com os princípios e finalidades da educação profissional e tecnológica, em articulação com o mundo do trabalho e os segmentos sociais, e com ênfase na produção, no desenvolvimento e na difusão de conhecimentos científicos e tecnológicos;
II. estimular e apoiar processos educativos que levem à geração de trabalho e renda e à emancipação do cidadão na perspectiva do desenvolvimento socioeconômico local e regional;
III. realizar ações voltadas, preferencialmente, para a população em situação de risco, colaborando para a diminuição das desigualdades sociais por meio da indicação de soluções para inclusão social, geração de oportunidades e melhoria das condições de vida;
IV. estabelecer ações de formação inicial e continuada de trabalhadores e da população em geral, na perspectiva de melhoria da qualidade de vida;

V. colaborar para o firmamento da identidade institucional do IFNMG, desempenhando papel de agente transformador da realidade local e regional;
VI. integrar o Ensino e a Pesquisa com as demandas da sociedade, seus interesses e necessidades, estabelecendo mecanismos que inter -relacionem o saber acadêmico e o saber popular.
I. contribuir para o desenvolvimento da sociedade, constituindo um vínculo que estabeleça troca de saberes, conhecimentos e experiências para a constante avaliação e vitalização da Pesquisa e do Ensino;
II. promover e fortalecer as relações entre os campi do IFNMG;
III. promover ações sociais;
IV. estimular a cultura;
V. apoiar atividades de pesquisa, desenvolvimento e inovação no âmbito do IFNMG;
VI. ofertar cursos de qualificação profissional (Formação Inicial e Continuada – FIC) para a comunidade externa e interna;
VII. promover eventos de Extensão para a comunidade externa e interna do IFNMG;
VIII. prestar assistência técnica e consultorias para o mundo produtivo;
IX. prospectar e divulgar estágio e emprego aos discentes e/ou egressos;
X. contribuir com o desenvolvimento dos empreendimentos locais e regionais(rurais e urbanos);
XI. sistematizar visitas técnicas e gerenciais de alunos e professores às empresas/instituições;
XII. participar, junto com os campi, do processo de definição da política de apoio estudantil, nas áreas educacional, social e da saúde;
XIII. estimular o uso dos recursos naturais de forma responsável;
XIV. manter e buscar novas parcerias com instituições públicas, organizações não governamentais, entidades do “Sistema S” e empresas privadas para uma atuação conjunta, no sentido de desenvolver ações extensionistas;
XV. articular políticas públicas que oportunizem o acesso à educação profissional, estabelecendo mecanismo de inclusão;
XVI. captar recursos, tanto na área pública quanto na área privada.
Confirmando tais concepções, o IFNMG tem como objetivos:Maylon Breno
Não há situação tão complicada que não possa ser enfrentada quando há cabeças dispostas a pensar e mãos preparadas para tornar o pensamento realidade. A situação é o segundo semestre do ano 2021, ainda abalado, sofrido e necessitado, agora não só pela pandemia da Covid, como também por seus efeitos fortemente sentidos na economia. As cabeças e mãos são a nossa comunidade acadêmica, que segue “extendendo” seu trabalho incansável em prol de nosso público interno e externo.
Que dizer a cada um dos servidores, alunos, colaboradores que nunca deixam seus projetos e continuam, prosseguem, permanecem servindo a instituição? A Contação é nossa maneira singela de agradecer, por meio da publicação de relatos, a todos que contribuem para que a esperança permaneça no coração daqueles que são atendidos em cada um dos planos que são realizados com tanto amor. Nesta edição, veremos alguns
trabalhos que representam uma pequena parte do que a Extensão, em parceria com as demais pró-reitorias, proporcionou aos cidadãos de nossa região: atendimento, conhecimento, oportunidades, arte, cultura, esporte, saúde e, não menos importante, aquele calor humano, aquele bate-papo, mesmo virtualmente, de que tanto necessitamos naquele momento.
Destaque nesta edição para a participação da equipe da Proexc, junto com docentes e acadêmicos, do Projeto Rondon, o maior projeto extensionista do país, em 2022. E, mesmo sendo calouros no evento, atuaram com brilhantismo e são motivo de orgulho para este IFNMG. E assim prosseguimos, com 2023 às portas, com a certeza de que nossos acadêmicos, professores e servidores continuam em suas atividades, com dedicação e esforço, pensando em como fazer com que as oportunidades permaneçam chegando a praticamente metade do Estado de Minas Gerais.
Que a leitura deste exemplar seja deleitosa para todos!

ARevista Contação, fruto da interação dialógica entre instituição e comunidade, reúne relatos sobre ações extensionistas realizadas por todos os campi do Instituto. Esta edição está ainda mais especial; além das narrativas dos projetos de extensão, teremos um relato emocionante sobre a primeira participação do IFNMG no Projeto Rondon e também uma seção especial para a apresentação dos projetos artísticos e culturais, realizados em todos os campi, sob a supervisão da “Coordenação de Cultura, Arte, Desporto e de Memória”, da PROEXC.
O IFNMG, por meio dos projetos de extensão realizados em 2021, efetivou o seu compromisso social de produzir conhecimento e, por meio desse, propor soluções para a superação das desigualdades sociais. Os diferentes saberes da comunidade foram acolhidos por meio de projetos que contemplaram, entre outros, grupos de estudos, clubes de leitura, capacitações tecnológicas, cursos preparatórios e, mais uma vez, comprovamos que uma educação de qualidade pode ser realidade de diferentes modalidades educativas.
Esta edição trará ainda importantes relatos de iniciativas que tiveram como objetivo principal a equidade e o respeito às diferenças. A nossa região é plural pela diversidade de crenças religiosas, etnias, culturas e, por isso, projetos extensionistas que contemplem assuntos como cotas raciais, pertencimento étnico-racial, direitos humanos, equidade e respeito à diversidade estarão sempre presentes na Revista Contação.
EditorialOutras iniciativas que a Revista traz reforçam o compromisso institucional do IFNMG de contribuir com o meio ambiente e desenvolvimento regional. Coleta seletiva de materiais recicláveis, revitalização de microbacias, recuperação de empreendimentos afetados pela pandemia, incremento da mão de obra e da economia do agricultor são alguns desses trabalhos que vocês verão por aqui.
Destacamos ainda a participação primorosa do IFNMG no Projeto Rondon. Considerado o maior projeto de extensão universitário do país, o Rondon visa a busca de soluções que contribuam para o desenvolvimento sustentável de comunidades carentes e ampliem o bem-estar da população, a partir da participação voluntária de estudantes do ensino superior. Nesta edição, vamos ler os relatos dos primeiros rondonistas da nossa instituição. Com certeza, você se emocionará!
Na última seção, você terá a oportunidade de experimentar uma viagem pelos trabalhos realizados pelos nossos artistas. São poemas, fotos e pinturas que retratam a sensibilidade dos nossos artistas e alimentam a nossa alma e os nossos corpos.
Esta revista é para você, que acredita que uma educação de qualidade pode ser realizada em diferentes espaços. Esta revista é para você que acredita que a educação vai além daquilo que é aprendido dentro da sala de aula. Enfim, esta revista é para você que preza, antes de tudo, pela pessoa humana, pela sensibilidade e, principalmente, pela inclusão social por meio do conhecimento extensionista.

 Lavoura de videiras em produção no município de Teófilo Otoni - MG
Lavoura de videiras em produção no município de Teófilo Otoni - MG
Reitora
Joaquina Aparecida Nobre da Silva Pró-Reitor de Extensão e Cultura
Rony Enderson de Oliveira
Diretora de Extensão Tecnológica Karine Alencar Fróes
Núcleo de Relações Interinstitucionais e Comunitárias
Célia Lopes Azevedo
Núcleo de Relações com o Mundo do Trabalho e Educação Profissional, Técnica e Tecnológica
Cláudio Marcio Dias Ferreira
Leonardo Estefanini Barreto
Coordenação de Cultura, Artes, Desporto e Memória
Warley Souza Dias
Coordenação de Programas, Projetos e Registros
Thatiane Lopes Oliveira Ivânia Gonçalves Dias
João Paulo Gonçalves Ferreira Núcleo da Educação do Campo Tania Maria Mares Figueiredo Núcleo de Centro de Línguas Thiago Lamonier Souza Gomes
Diretores/Coordenador de Extensão dos Campi Campus Almenara
Ronivaldo Ferreira Mendes Campus Araçuaí
Vanessa Gomes de Castro Campus Arinos
Valdeir Antonio da Silva Campus Diamantina
Hannah Serrat de Souza Santos Campus Avançado Janaúba
Marco Aurélio Oliveira Dias Campus Januária
Giuliano Viana de Alkimim Campus Montes Claros
Mario Sérgio Costa Silveira Campus Pirapora
Daniel Rocha Silva Campus Avançado Porteirinha

Alysson Frederico Gonçalves Santos Campus Salinas
Ricardo dos Santos Silva Campus Teófilo Otoni Leonardo Rodrigues da Costa
Revista de Extensão

Nº. 8 - Dez/2022 ISSN 2447-3480
Coordenadora de Produção Editorial
Thatiane Lopes Oliveira Revisora
Luciana Lacerda de Carvalho Programador Visual e Diagramador Marcos Aurélio de Almeida e Maia Título da Revista Bráulio Quirino Siffert Foto de Capa
Zélia Natália Fonseca Torres Fotos da 2ª, 3ª e 4ª Capas Francisco Bezerra Coordenador de Produção Gráfica Gustavo Henrich E. Vieira
Tiragem: 600 Circulação: Nacional Periodicidade: Anual Impressão: CSS Editora Gráfica
Reitoria do IFNMG
Rua Professor Monteiro Fonseca, 216 Vila Brasília - Montes Claros/MG CEP: 39400-106 Fone: (038) 3218-7300 www.ifnmg.edu.br facebook.com/ifnmgoficial instagram.com/ifnmg_oficial
Norte de Minas Gerais
16

IFNMG no Projeto Rondon 22 Depoimentos dos alunos rondonistas 28 Projetos Artísticos, Culturais e Esportivos 30 Mapa das culturas do IFNMG: Identificação e divulgação dos agentes, eventos, projetos e espaços culturais na área de abrangência do IFNMG Campus Diamantina 33 Extensão, pesquisa e oportunidades: mídias digitais e protagonismo estudantil a serviço da divulgação 36 Clube de leitura “Sagarana” 41 Grupo de estudos Maria Firmina dos Reis: relações étnico-raciais e educação 44 Clube de leitura IFNMG Campus Salinas: da leitura individual à construção de uma comunidade leitora 48 Meu cerrado de asas e flores: observação e registro fotográfico no Campus Arinos 52
Projetos Sociais 54 Pragas Urbanas: Bichos SA 58 Implementação das cotas raciais no IFNMG-Campus Salinas: discutindo a (in)visibilidade dos alunos cotistas raciais 61 Projeto acompanhamento de egressos 66 Saúde do adolescente e os desafios de uma nova geração 70 Capacitação que Transforma 74 Expressa juventude: identidades e narrativas plurais 80 Pré-técnico 2018 83 Qualidade do ar ambiental em comércios da cidade de Januária-MGconscientização para prevenção de doenças infecciosas de transmissão aérea 85 Conscientização e demonstração da eficiência da higienização das mãos no controle da COVID-19 em instituições de ensino do município de Januária-MG 88
Projetos de Extensão Tecnológica 90
IF mais Empreendedor: Recuperação do Impacto da Pandemia de COVID-19 93 Projeto Rio Vivo 97 Implantação do campo agrostológico 100 Projeto Frutificar 103 Desenvolvimento de jogo educacional digital para auxiliar no processo
Contação - Aprende-se ensinando nos Vales e Gerais
de ensino aprendizagem de Matemática
105 Ações de sustentabilidade ambiental com ênfase nos resíduos sólidos no IFNMG Campus Januária
110 Ações de sustentabilidade e educação ambiental no município de Itacarambi-MG com ênfase nos resíduos sólidos
115 Projeto Reciclaê: Desenvolvimento de aplicativo e ações de conscientização da população para realização da coleta seletiva de materiais recicláveis em Salinas -MG
118 Seção Arte e Cultura
120 IF Mundo 2019 - Simulação da ONU no IFNMG 122 III Mostra de Dança e II Mostra de Linguagens 124 96%
126 Casa de família 128 Sagrada Família do Vale Jequitinhonha 130 Alice
132 O que eu sou?
134 Saudade de Arinos 136 Arquitetura 138 Tato
140 Do beco pro céu 142 Cantando o Gorutuba 146 Núcleo de Estudos Afro-Brasileiros e Indígenas (NEABI) 154 Lembranças de um estudante 156 Artes Visuais
162 Novembro da consciência negra 164 Jogo de cartas marcadas
166 A ponte, as garças e o majestoso Velho Chico 168 Lumar 170 Espaço 172 Dona Helena

176 Zeus e Antíope ou raízes do Brasil
178 Papai, por que você vai trabalhar?
180 Beleza Negra 182 Orquídea Phalaenopsis Branca 184 [Sem título]
186 Somebody That I Used to Know 188 Sarau Cultura de Primavera
 Encerramento da Operação Rondon das Minas Gerais
Encerramento da Operação Rondon das Minas Gerais

Criado em 1967 e coordenado pelo Ministério da Defesa em parceria com outros Ministérios, entre eles o Ministério da Educação, o projeto Rondon é o maior projeto de extensão universitária do país, com o objetivo de levar a juventude universitária para conhecer a realidade multicultural e multirracial do Brasil. Possui também o propósito de levar conhecimento acadêmico para além dos muros das instituições de ensino superiores (IES), além de oferecer conhecimento e oportunidade de contribuir para o desenvolvimento social e econômico das regiões mais carentes do país. De 1967 a 1989, ano em que foi extinto na gestão do então pre -


Pela primeira vez, o IFNMG participa do Projeto Rondon, maior projeto extensionista do Brasil
sidente da época José Sarney, as ações do projeto Rondon eram de caráter assistencialista. Em 2005, quando o projeto é relançado pelo Governo Federal, graças ao apelo da União Nacional dos Estudantes (UNE), o projeto Rondon volta com suas ações focadas em disseminar conhecimento para a formação cidadã e formar multiplicadores das ações do projeto.
O Instituto Federal do Norte de Minas Gerais, por meio da Pró-Reitoria de Extensão e Cultura, participou, pela primeira vez, desse exitoso Projeto. A Operação Rondon das Minas Gerais ocorreu entre os dias 30/06/2022 e 17/07/2022, simultaneamente, em 12 municípios do Norte de Minas Gerais ( Botumirim/MG, Campo Azul/MG, Cristália/ MG, Engenheiro Navarro/MG, Grão Mogol/MG, Ibiaí/MG, Ibiracatu/MG, Josenópolis/MG, OlhosD’Agua/MG, Ponto Chique/MG, Ubaí/MG e Varzelândia/MG).

O IFNMG atuou no município de Ibiracatu/MG e, durante todo o pe -
ríodo, oito discentes previamente selecionados e capacitados e dois docentes ofertaram oficinas e minicursos nas mais diversas áreas como: meio ambiente, saúde, informática, comunicação, direito e legislação, dentre outras.
Essas oficinas foram previamente planejadas, levando em consi-
deração o levantamento realizado durante uma viagem precursora, realizada no mês de maio/22. Nessa etapa foi possível conversar com todos os representantes do município (prefeito, secretários municipais, professores, profissionais da saúde, religiosos, comunidade da zona urbana e rural…) e realizar

um diagnóstico do município. Esse levantamento foi essencial para o alinhamento das necessidades dos munícipes e as oficinas a serem ofertadas.
Foram atendidas, diretamente, 1453 pessoas, com a realização de 20 diferentes oficinas realizadas nos três turnos (matutino, vespertino e noturno), durante todo o período da Operação, além de visitas domiciliares. A Operação Rondon das Minas Gerais impactou, diretamente, mais de 40 mil pessoas e estima-se
que mais de 140 mil pessoas foram beneficiadas indiretamente
O professor Pedro Fábio, que participou como coordenador adjunto da operação, considera essa participação no Rondon como um marco na história da instituição. “ O IFNMG tem muito a se orgulhar, tive a honra e o orgulho em participar de forma pioneira junto com uma equipe extraordinária composta por dois professores, oito alunos e mais três representantes da Pró Reitoria de Extensão. É difícil colocar em pa-

lavras todas as sensações, sentimentos e a emoção em participar do Rondon, somente vivenciando a experiência pra saber. E ter o seu nome entre a equipe que vivenciou essa experiência incrível é realmente motivo para se orgulhar”, relata o professor.
Para a professora Patrícia Conceição Medeiros (coordenadora da Operação Rondon Minas Gerais) a participação do IFNMG foi muito exitosa. A instituição ganhou lugar de destaque ao ser classificada em
Contação - Aprende-se ensinando nos Vales e Gerais
primeiro lugar no “Conjunto B: Comunicação, Meio Ambiente, Tecnologia e Produção e Trabalho’’, o que reflete a qualidade e excelência dos projetos de extensão desenvolvidos notadamente nos eixos de Meio Ambiente, Informática e Comunicação, que nortearam as oficinas do projeto. “Embora tenhamos enfrentado todos os desafios e dificuldades de uma participação pioneira, foi um diferencial significativo a entrega, comprometimento e dedicação dos 8 alunos rondonistas, dos campi Januária, Porteirinha e Salinas. Eles foram protagonistas da operação em todos os momentos. Destaca-se também a contribuição dos gestores, líderes locais e comunidade em geral do município de Ibiracatu-MG; a parceria com a Universidade Federal do Rio Grande Sul e a iniciativa da Pró-reitoria de Extensão do IFNMG. Espero que a nossa participação inspire outros colegas a participarem e coordenarem as próximas operações”, ressalta a professora.


(Bacharelado em Sistemas de Informação - Campus Avançado Porteirinha)
“É difícil descrever o Projeto Rondon em palavras, é uma experiência que deveria ser vivida e sentida por todos. Eu tive o privilégio de viver o Rondon nas suas duas esferas, primeiro como participante de oficinas aos 16 anos, onde carreguei comigo a lembrança daqueles alunos de chapéu e camisa amarela tão característica e que nos passaram tanto durante as oficinas, e agora aos 23 anos, realizei um sonho voltando ao Projeto Rondon como Rondonista. É um sentimento ímpar, quando eu soube do edital de seleção dos Rondonistas do IFNMG para essa operação, eu não pensei duas vezes, eu simplesmente queria ir, queria viver essa experiência, queria compartilhar o pouco que eu sei, queria disseminar um conhecimento que poderia ser válido e aproveitado pelos moradores de Ibiracatu - MG. Ah, eu não estava preparado para o que o Rondon é, não estava preparado para receber tanto daquela cidade tão hospitaleira e bonita, ao chegarmos na cidade, ao ver aquela recepção… simplesmente nos deixa sem palavras, mas como diria nossa Professora Coordenadora Patrícia: “o sentimento é de gratidão e de dever cumprido!” , e como disse também nosso Professor Coordenador Adjunto Pedro: “Estamos fazendo história!”. Foi incrível, a troca de conhecimentos que tivemos com a população foi gigantesca, e digo sem medo de errar, que aprendemos mais com eles, do que eles com nós. Cada oficina, cada história ouvida, cada sorriso, é único e torna o Rondon também único e especial. Eu só tenho a agradecer ao IFNMG, a Pró Reitoria de Extensão e Cultura e a essa equipe maravilhosa, que vou guardar pra sempre no coração pois foi “do Rondon pra vida”. Termino esse texto reafirmando a minha imensa gratidão para com todos os envolvidos nesse projeto maravilhoso.”

“Participei do Projeto Rondon como espectadora, na cidade em que cresci, quando tinha apenas 7 anos, desde então nunca me esqueci do nome e do característico chapéu, a marca do Rondon. Assim que soube que o IFNMG participaria do projeto logo quis me inscrever, pois apesar das experiências que ganharia seria também a realização de um desejo da minha infância, ser uma rondonista. E somente sendo um(a) rondonista, estando do outro lado de fato é que vemos a magnitude do projeto e o quanto é transformador, unindo pessoas de todos os lugares, com os mais variados sotaques com um único propósito, promover a cidadania! E que gratificante é fazer extensão, poder levar seu conhecimento para outras pessoas, conhecê-las, ouvir suas histórias e ver os seus olhos brilhando ao aprender algo novo a cada oficina.
Achávamos que somente nossas oficinas pensadas cuidadosamente para a população que ensinariam, mas cada lugar visitado, cada pessoa que nos recebia em suas casas, nos encontrava pela rua, ou até mesmo durante as oficinas, nos ensinava algo também, e nada melhor do que essa troca de experiências, a cidade de Ibiracatu-MG além de nos acolher tão bem, nos ensinou muito. O Projeto Rondon, além de possibilitar viver experiências únicas, conhecer pessoas incríveis, possibilitou enxergar um Brasil, um norte de Minas, além dos muros da nossa Instituição de Ensino, nos fez sair da zona de conforto, conhecer nossa gente e sua realidade, nos mostrando o que é humanidade e nos ensinando uma verdadeira Lição de Vida e Cidadania, contribuindo não só na minha formação acadêmica, mas principalmente na minha formação em gente!
Contação - Aprende-se ensinando nos Vales e Gerais
“O Rondon sem dúvidas transformou a minha vida, foi uma experiência linda, grandiosa e honrosa, que o IFNMG me proporcionou sem dizer que foi absolutamente incrível ser uma das alunas a integrar o time de primeiros rondonistas da instituição. Sou muito grata pela oportunidade e por ter feito parte de um time excelente formado por alunos e professores do IFNMG, a nossa equipe sem dúvidas brilhou muito.

A oportunidade de levar meus conhecimentos acadêmicos até a comunidade e de propor ações de melhoria na qualidade de vida das pessoas foi indescritível, aprendi no Rondon que conhecimento só é conhecimento quando compartilhado, que meus conhecimentos não é nada quando se compara com o das pessoas da comunidade ainda me arrisco a dizer que o conhecimento só se concretiza quando adaptado para a realidade que estamos inseridos, confesso que minhas expectativas para o Rondon não eram grandes coisa mas, fui incrivelmente surpreendida pela grandiosidade do projeto, do significado e do impacto do projeto na vida das pessoas. Gostaria de salientar que a doce e gentil cidade de Ibiracatu- MG me mostrou que gentileza, simplicidade e generosidade são as melhores coisas para se oferecer a um visitante, ainda me arrisco a dizer que as pessoas são as melhores lembranças que pode levar de um lugar. O projeto Rondon tem um pedaço de mim, assim, como existe em mim um pedaço dele e eu sou grata por isso! Grata pela cidade de Ibiracatu pela recepção, grata a minha equipe, grata pelas pessoas que conheci, pelos sorrisos, pelas belíssimas histórias que ouvi, pelos incontáveis aprendizados, e pela oportunidade de ter vivido tudo que o Rondon me proporcionou.”
“No dia 30/06/22 embarcamos, com uma agenda cheia de planos e o coração cheio de vontade de fazer a diferença, onde pude participar de uma das experiências mais transformadoras da minha vida, que é o projeto Rondon. Foram momentos de muito aprendizado, superação e alegria. Aprendi com pessoas que se dedicam dia após dia para fazerem seus trabalhos, com as crianças e jovens que têm sonhos e querem mudar de vida e com os meus colegas, professores e estudantes, que se tornaram minha família. O Projeto Rondon não foi apenas uma experiência extracurricular para mim, sem sombra de dúvidas, como o próprio slogan do programa diz: foi uma lição de vida e de cidadania e sou eternamente grata por ter sido uma das estudantes selecionada para participar de tal. Foi um misto de emoções, de cooperação, amizade, acolhimento, seriedade, paciência, trabalho e dedicação. E o maior aprendizado que trouxe na bagagem, foi que não devemos abaixar a cabeça diante dos desafios e dificuldades. Por mais que você pesquise so -
bre o projeto, escute experiências de outras pessoas, a gente só tem noção do quão grande é o Rondon, quando chegamos ao Batalhão, onde fiquei deslumbrada com o carinho e cordialidade do Exército que esteve conosco em todos os momentos, principalmente ao nosso anjo Caroba.
Voltei desta missão com muito mais do que pude levar, sei que parece clichê, mas é a verdade: aprendemos muito mais do que ensinamos. Agradeço a toda à comunidade de Ibiracatu, cidade que foi nossa casa durante os dias de operação, que nos recebeu com tanto carinho, e que as sementes deixadas, sejam em breve grandes frutos para a sociedade. Agradeço também à professora Patrícia, por ter coordenado tão bem toda a operação. Se eu pudesse aconselhar um projeto pra todo mundo participar seria esse. Obrigada ao IFNMG, Ministério da Defesa e minha equipe por ter me proporcionado essa experiência incrível.
Uma vez Rondonista, sempre Rondonista!”
O que falar desse projeto grandioso? Me faltam palavras para expressar imenso amor e gratidão. Eu particularmente não conhecia o projeto Rondon, fui conhecer a partir de um anúncio de edital no instagram, por curiosidade, acabei pesquisando melhor sobre. Que oportunidade maravilhosa, pude vivenciar em ser uma das primeiras Rondonistas do IFNMG - Campus Januária. Viver o Rondon, foi algo avassalador, que permitiu a
troca de conhecimento, sabedoria, aprendizado e experiências, “ o que seria da humanidade sem a partilha do conhecimento”. Já dizia, Cora Carolina: “Feliz aquele que transfere o que sabe e aprende o que ensina”. Pois bem, foram os 15 dias mais impactantes da minha vida poder diariamente conviver com diferentes pessoas, etnias e culturas. Proporcionar a população com nossas ações, além de conhecer de perto cada rea-
lidade, sorriso, frustração. Isso é fazer extensão, estender a universidade para além dos seus muros. Vale ressaltar que, só vivendo para saber o quão gratificante é o rondon.
Hoje me passa um filme, do início de todo o projeto até aqui. Dos amigos, conhecidos, cidade contemplada. Que lindo! Agradecimentos a todos envolvidos. O Rondon, foi além de uma experiência extra curricular.
Reforçando a fala da nossa coordenadora da operação: “E se um dia me perguntarem o que eu fiz pelo meu país? Direi que fui Rondonista”.
Contação - Aprende-se ensinando nos Vales e Gerais

O Projeto Rondon foi, sem dúvidas, a melhor experiência da minha vida, tanto pelo lado pessoal quanto pelo lado profissional. Durante o período que ficamos na cidade de Ibiracatu pude conhecer pessoas e histórias maravilhosas. Foi uma honra ministrar cursos para a população e poder contribuir de alguma maneira para o crescimento das pessoas que residem naquela cidade. Tive o privilégio de ministrar os cursos para públicos de diferentes idades e a cada oficina ministrada eu sempre saia orgulhosa e com sensação de dever cumprido, ao ver a alegria das pessoas em estar

participando, aprendendo e contribuindo para o lugar em que eles vivem. Foi gratificante poder conhecer histórias que lembrarei para o resto de minha vida, histórias de superação e muita luta. A partir do momento que cheguei na cidade e comecei ministrar os cursos, percebi a grandeza do projeto Rondon e a sua importância para a vida das pessoas, principalmente das comunidades próximas a cidade de Ibiracatu, que eram comunidades mais carentes e que geralmente tinham muito interesse em aprender e repassar todos os ensinamentos. Vejo o IFNMG como
uma esperança para as pessoas daquele município, visto que é uma porta de entrada para os jovens de Ibiracatu e de toda a região do norte de Minas a terem condições de conseguir estudar e mudar as suas vidas. Percebendo isso, sinto muito orgulho de fazer parte dessa instituição que tanto promove melhorias para a vida das pessoas e estendo o meu orgulho ao projeto Rondon e a todos os rondonistas e pessoas que participaram do projeto e contribuíram de maneira grandiosa para a vida das pessoas que foram contempladas pelo projeto. Tal projeto mudou a minha forma de olhar para a vida e percebi a importância dos projetos de extensão para a sociedade.
O que dizer sobre a extensão? Pude estar em um ambiente completamente diferente com pessoas e histórias incríveis a qual não teria contato fora dos muros da faculdade. Às vezes nos prendemos aos livros, aos contos e esquecemos das pessoas, do convívio e de boas risadas, mas os projetos de extensão nos fazem alcançar e ter experiências que mudam nossa visão de mundo. Essa foi minha experiência no Projeto RONDON, desde o primeiro dia eu não tirei o sorriso do rosto, estive ao lado de pessoas excepcionais e que não poupavam esforços para fazer do trabalho um ambiente agradável. Além disso, o contato com diferen-
tes culturas nos proporciona uma ampliação do conhecimento, já que sentar em uma cadeira na casa de uma senhora e poder ouvir sobre sua história de vida, Ah, essa sensação não tem preço. Ouvir um “eu te amo” de uma criança, ou o agradecimento de um adulto com certeza é emocionante. As experiências que adquiri no RONDON foram de longe a melhor coisa que já me ocorreu, me fez ter um contato humano e me ensinou sobre valores aos quais eu não sabia que precisava. Obrigada IFNMG por me proporcionar tamanha experiência, só sei que todo aluno precisa passar por esse projeto, pois com certeza sairá transformado. Fomos os primei-
ros do Instituto e levarei essa honra no coração. Que saudade de acordar cedinho e super animada para mais um dia de trabalho, saudades de ver os amigos apressados, mas que no fim da noite tudo valeu a pena, essa palavra marcou no RONDON: SAUDADE!! Enfim, ganhei amigos, ganhei professores e ganhei memórias. Todo meu agradecimento aos representantes e em especial a Patrícia que não poupou esforços para fazer tudo isso acontecer… e pessoal (Bibi, Joyce, Zélia, Ana P., Ana C., Izaque e Kerles) Vocês são incríveis e nunca irei esquecer dos nossos momentos juntos. O projeto RONDON mudou completamente a minha vida.
Contação - Aprende-se ensinando nos Vales e Gerais

“Não posso falar do ROND ON sem antes descrever a importância do IFNMG em minha vida. O Instituto Federal mudou minha vida de uma forma tão gigantesca, onde aqui na nossa região os filhos de famílias carentes não tinha vez em fazer um curso superior, hoje essa realidade é bem diferente, estudar em uma instituição federal com ensino de qualidade e gratuito onde a própria instituição abre portas e caminhos dando oportunidades para que possamos crescer tanto profissional quanto pessoal. E um dos projetos do IFNMG é o de extensão, onde já tive a oportunidade de participar de alguns, um dos momentos que me marcou antes de irmos para a operação foi o nosso encontro na reitoria. Fomos recebidos de uma forma tão maravilhosa que me lembro quando nos apresentamos que éramos alunos do projeto Rondon a Taty e a Karine logo veio nos receber com tanto afeto, daquele momento em diante o coração ficou pequeno para tantas emoções. Fomos apresentados também para uma equipe que estava em reunião, sabem fazendo o quê? Sim, lutando pelos os nossos direitos, defendendo a pesquisa e a extensão, sair tão orgulhosa de mim mesma, que me

prometi que daquele dia em diante não quero menos para a minha vida, que eu posso ir além. Agora o RONDON é um sonho que o IFNMG me deu a oportunidade de realizar, já havia participado do projeto em 2014 quando teve na minha cidade, simplesmente fiquei encantada e fui passar a saber como é que fazia para ir para operação, mas naquele momento era apenas um sonho onde não realizaria nunca por que tinha que estar fazendo uma faculdade e essa realidade estava muito fora dos meus planos. Alguns anos depois estou estudando em uma instituição federal onde a mesma fica em primeiro lugar do maior projeto de extensão do Brasil que um dia tanto sonhei em participar. O Rondon vai muito além, além de uma sala de aula é uma mistura de sentimentos, trocas de conhecimento, só vivenciando para saber. É uma renovação na nossa vida, onde você vai com um conhecimento e volta enriquecido de novas experiências, novas amizades, novo jeito de ver a vida. O Rondon meu deu pessoas que levarei por toda a minha vida, a Professora Patrícia quanta maestria, nos conduzia e nos estimulava todos os dias, ela é minha musa inspiradora. O professor Pedro sempre nos moti-
vando, “vocês são os melhores, vocês são os protagonistas da operção…”. As meninas(Gaby, Sandy, Joyce, Tia Zélia, Paulinha e Karol ) são minhas meninas. O Izaque, quanta garra e determinação, nos desdobramos nas oficinas para poder conseguir atender mais pessoas. Sem esquecer do município que nos acolheu Ibiracatu-MG, fomos recebidos com foguetes, já tinham uma equipe toda preparada para cuidar da gente. Cada lugar que passamos, cada pessoa que ali conhecemos, deixamos um pouquinho de nós, eu tive a oportunidade de contar um pouquinho da minha história que tanto tenho orgulho, compartilhar com os jovens que estão saindo do ensino médio sem perspectiva nenhuma, mostrando que sim é possível que depende do meu eu, EU POSSO, EU QUERO tudo se torna mais fácil, e aprendemos muito com eles, o Rondon é isso é levar mas também estar preparado para receber. Enfim a palavra que me define é GRATIDÃO, a Deus por ter me proporcionado e me capacitado por este momento, ao IFNMG por acreditar em mim e realizar junto comigo o meu sonho. E sem deixar de agradecer a Rony por também carregar esse sonho do IFNMG no RONDON. Ser uma das primeiras rondonistas do IFNMG foi muito além do meu sonho. Fizemos História.”


Coordenador: Gregório Hernández Pimenta
Discentes bolsistas: Rayane Aparecida Almeida e Jamille de Oliveira
Colaboradora: Marli Silva Froes
Autor do relato de extensão: Gregório Hernández Pimenta Campus: Diamantina Públicos-alvo: Grupos Comunitários e comunidade externa Período: 01/10/2021 a 31/03/2022
Diferentes artistas e equipamentos culturais de Diamantina e região foram cadastrados em uma plataforma digital, possibilitando a divulgação dos mesmos e o fortalecimento da cultura local.

Entre os meses de outubro de 2021 e abril de 2022, vários campi do IFNMG desenvolveram a versão local do projeto “Mapas de cultura do IFNMG”, que teve, como objetivo, cadastrar agentes culturais, eventos, projetos e espaços culturais da área de abrangência de cada campus, em uma plataforma digital. Com isso, esperava-se dar visibilidade para os diversos artistas, grupos e coletivos da região e oferecer um espaço virtual que concentrasse informações sobre a produção artístico-cultural da cidade e seu entorno.

No Campus Diamantina, os artistas foram descobertos pela troca de informações entre coordenadores,
bolsistas e informantes locais. Esse processo auxiliou a construção de listas de agentes culturais e a expansão do repertório dos bolsistas, que
Captura de tela com o mapa de Diamantina e todos os cadastros realizados
puderam conhecer novos trabalhos artísticos.
Coube aos bolsistas estabelecer a comunicação com o artista e realizar
Contação - Aprende-se ensinando nos Vales e Gerais
Captura de tela de uma reunião online de orientação das bolsistas

o cadastro no site. Devido à pandemia, o contato teve de ser feito, estritamente, por meio digital, o que, de acordo com a bolsista Jamille de Oliveira, foi uma das dificuldades do trabalho: “um dos grandes desafios de estar em um projeto de extensão na pandemia é que a tecnologia que ajuda a encontrar várias pessoas é a mesma que te afasta de outras; a internet é assim, é facilitadora, mas também distancia grande parte das nossas relações interpessoais.”
Avaliamos que a limitação imposta pela tecnologia influenciou bastante o número final de agentes cadastrados em relação aos agentes contactados. Foram 55 contatos, dos quais somente 18 foram efetivamente cadastrados no site. Tendo em vista essa limitação, ao final do projeto, acabamos nos concentrando no cadastramento de espaços/ equipamentos culturais e finalizamos o projeto com 25 cadastros dessa categoria no mapa.
Um aspecto que ficou evidente durante o desenvolvimento do projeto foi que alguns artistas não têm a dimensão do quão potente é a sua arte e que, por isso, precisa ser divulgada. Conforme relata a bolsista Jamile de Oliveira “lembro-me de conversar com uma escritora que achava que não poderia participar, porque

‘não trabalhava com arte, só com escrita’. Por outro lado, aprendemos com alguns artistas a necessidade da superação das dificuldades, do preconceito e da desvalorização. Fica a lição da resistência, perseverança e, acima de tudo, esperança na arte. O Mapas das Culturas me fez criar laços, conhecer histórias e, principalmente, reaprender o que é cultura”.”
Atuar em um projeto de extensão com a temática da arte e da cultura trouxe vários aprendizados e experiências importantes para as bolsistas do projeto. Segundo a bolsista Rayane Almeida, a experiência de atuar em seis meses do projeto “Mapas das culturas” lhe permitiu “a ampliação da noção de cultura, de produtos culturais e do próprio artista, noções as quais desconhecia. Fica o aprendizado de que há vários artistas transformando seu mundo em arte e que não têm tanta visibilidade”.


Jamille, ao relatar sobre seu aprendizado no projeto, destaca: “Algo que me marcou durante o projeto foi poder fazer trocas com
as pessoas que íamos contactando e conversar com elas. E essa troca nos permitiu também ensinar, a partir do que aprendemos e vivenciamos no projeto, que há diversas formas de expressões artísticas; foi muito valioso tanto para nós como bolsistas, como também para a comunidade local”.
O projeto foi desenvolvido em diversos campi do IFNMG e as informações ainda podem ser vistas no site oficial. Reforçamos que a busca por integrar a comunidade nos campos artístico e cultural é de extrema importância para a sua valorização. Uma comunidade que conhece a sua cultura conhece a sua história.
Contação - Aprende-se ensinando nos Vales e Gerais
RESUMO: Bolsistas e comunicadores de sete diferentes campi do IFNMG produziram vídeos, fotos, peças gráficas e outras ações de comunicação para as redes sociais oficiais dos campi e da Reitoria, ampliando e diversificando o diálogo com o público externo e o alcance das informações, oportunidades e serviços da instituição.


As redes sociais são, para boa parte das instituições, incluindo o IFNMG, umas das principais maneiras de dialogar com os diferentes públicos e divulgar as informações, oportunidades, serviços e ações. Nesse sentido, o projeto de extensão colocado em prática pelos comunicadores do IFNMG, no segundo semestre de 2021, buscou promover uma atuação mais intensa nas redes, com uma linguagem mais direcionada e adequada, potencializando a divulgação do Instituto e estimulando o protagonismo dos estudantes e a busca por uma comunicação mais colaborativa e integrada entre as diferentes unidades do Instituto.
O mundo se transformou e é de extrema importância que as instituições acompanhem essa transformação, de forma a alcançar os
Vídeo informativo feito por estudante do Campus Arinos
Coordenadores: Braulio Quirino Siffert, Cleiton Lisboa Mota, Hermílio Daniel Prates, Marcos Vinicius Montanari, Gersiane Franciere Freitas Ribeiro, Paula Assis Martinez, Guilherme Mendes de Almeida Carvalho e Priscila Castro
Bolsistas: Ana Clara Leal Pires, Eduarda Cristinny Almeida Araújo, Maria Luisa Silva Rosa, Thamyres de Matos Costa, Laysla Morais Martins da Silva, Sarah de Oliveira Vieira, Ana Julia Abrantes, Camila Dia Rodrigues de Sá, José Wilson Ferreira Bispo, Kauã Martins de Sá, Lídia Helaine Rodrigues Ferreira, Otávio Gomes Miranda e Ana Júlia Santos
Discentes voluntárias: Laís Matos Tudéia e Viviane do Nascimento Santos
Colaboradores: Lais Galliac Queiroz Jardim, Luan Diego de Lima Pereira, Thiago José Policarpo Firmo Santos, Evandro dos Anjos, Ellen Krystine Motta, Fábio Simão e Fernando Macedo
Autor do relato de extensão: Bráulio Quirino Siffert Campus: Almenara, Arinos, Diamantina, Montes Claros, Porteirinha, Salinas, Teófilo Otoni E Reitoria Público-alvo: Comunidade externa Período: 01/07/2021 a 12/12/2021
jovens com uma linguagem mais apropriada. A atuação dos bolsistas, que fazem parte do público-alvo
e dessa geração já nascida nas redes sociais foi fundamental, tendo em vista que trazem a linguagem, a vivência e os interesses próprios desses jovens, conseguindo comunicar-se com estudantes e futuros estudantes de forma mais eficaz.

O mesmo modelo do Projeto, ou com algumas diferenças foi realizado em sete campi do Instituto, sob a coordenação dos servidores responsáveis pela comunicação em cada unidade. Ao Departamento de Comunicação, na Reitoria, coube articular um contato entre todos os campi, promover ações conjuntas e integrar os bolsistas em produções de todo o IFNMG, a exemplo da campanha de divulgação do processo seletivo.
No Campus Diamantina, por exemplo, os bolsistas propuseram e participaram efetivamente da construção de ações de divulgação, como a realização de uma série de

Vídeo com médico do Campus Arinos sobre variantes da Covid-19

Postagem feita por bolsistas do Campus Diamantina em comemoração ao dia do professor
vídeos que trouxe o relato de servidores acerca de assuntos importantes do campus. Trouxeram também suas experiências nas redes sociais, trazendo uma linguagem “jovem e atual” para as publicações. Todos os encontros foram muito produtivos e geraram discussões interessantes sobre a necessidade do protagonismo estudantil nos processos comunicacionais.

O vídeo sobre o processo seletivo que foi elaborado, executado e editado pelos próprios bolsistas do projeto no Campus Teófilo Otoni chegou a ter quase 6 mil visualizações nas redes sociais, um alcance que a divulgação tradicional não costuma ter. Segundo os bolsistas do projeto, levar as ações do campus para o mundo virtual é fundamental, principalmente, considerando aquele momento de pandemia e distanciamento social.
No Campus Arinos, o projeto atuou nas redes sociais com informações para a comunidade sobre pesquisas, dados e dicas relacionadas à prevenção à Covid-19, além de incentivar a todos a saberem lidar com a situação sem prejudicar a saúde e o bem estar. Para isso, foram produzidos mais de 30 posts, entre vídeos e banners, com dicas para melhorar a imunidade; esclarecimentos sobre as variantes e dúvidas decorrentes do aparecimento destas; promoção de material informativo das agências de saúde sobre a pandemia; dicas de alimentação, exercícios físicos; como manter a saúde mental durante o período, entre outras.
Assim, percebeu-se que, nos diferentes trabalhos nos diferentes campi, os resultados foram semelhantes: maior diversificação das publicações, oxigenação da equipe de servidores, troca de experiências, relacionamento direto com o público externo e aprendizado e protagonismo por parte dos estudantes.
Coordenador: Pedro Henrique Prado da Silva
Discentes Bolsistas: Letícia Costa e Ana Julia Teles
Colaboradora: Nádia Bueno Rezende
Autor do relato de extensão: Pedro Henrique Prado da Silva Campus: Teófilo Otoni Públicos-alvo: Adolescentes, jovens, adultos e idosos Período: 17/09/2021 à 17/01/2022
Você sabe quais os benefícios de ler as obras clássicas da literatura? Saberia dizer a diferença entre obras clássicas e os outros tipos de obras literárias? Haveria mais vantagens em ler os clássicos comparados aos outros tipos de obras? Estas e outras perguntas foram o gatilho para dar início a esse projeto cujo foco foi a valorização da cultura literária.
or que ler os clássicos?” A mesma pergunta feita por Ítalo Calvino (2007) nos provocou ao longo de todo o período de desenvolvimento das atividades do “Clube de Leitura ‘ww’”, projeto oriundo do Campus Teófilo Otoni, destinado a atender um público variado da comunidade externa e interna do IFNMG e cujo propósito principal foi estimular a leitura daquilo que estávamos chamando de “clássicos” da literatura nacional e estrangeira. No início, a pergunta ficou sem resposta, mas o que nos espantou foi percebermos quão desajeitada era a categoria que estávamos mobilizando para definir o objetivo do
grupo, uma categoria pouco atrativa, sobretudo para um público mais jovem (não é rotineiro vermos adolescentes e jovens fãs de música clássica, por exemplo); além disso, o fato de não ser uma categoria bem definida geraria confusões sobre os nossos próprios interesses com o projeto.
Essa última advertência surgiu logo no planejamento do cronograma de leituras pelos integrantes, quando frisaram que, para eles, a ideia de “clássico” remetia a obras históricas e antigas, ou, ainda, a obras vinculadas à cultura erudita. Não havia razão, para nós do projeto, submeter a escolha das obras para a leitura a partir deste conceito sobre “clássicos”; aliás, era do nosso
interesse ler obras mais atuais, de autores contemporâneos, e estimular a leitura de livros oriundos da cultura popular, com os quais poderíamos perceber traços das tradições e costumes populares. Cá pra nós, um projeto que leva em seu nome o título da obra de Guimarães Rosa, na qual predomina a vida comum do sertanejo (e, por vezes, de homens e mulheres do Norte de Minas Gerais), não haveria razão de existir com o propósito único de formar eruditos. Por isso, nossa alternativa foi entender as obras clássicas como sendo aquelas que se diferenciam das obras produzidas pela indústria cultural (estas, com o propósito de subsidiar o mercado literário, convencionalmente conhe -
Contação - Aprende-se ensinando nos Vales e Gerais

cidas como best sellers – algo similar aos livros de Harry Potter, Saga Crepúsculo, as obras do autor Dan Brown, entre outras). Evidente que não condenamos quem lê esse tipo de literatura – para nós, ler é bom em qualquer circunstância! Contudo, precisávamos sublinhar um aspecto próprio do grupo para justificar sua relevância. Então, “clássico” é um rótulo que escolhemos para aprimorar nossos propósitos e, em torno deste rótulo, agrupar pessoas que compartilhem do mesmo interesse de leitura.

Dessa maneira, e superada essa parte mais complexa, o nosso grupo elaborou um cronograma de leituras e reuniões, que compreendeu o período de setembro de 2021 a janeiro de 2022. Nesse primeiro momento, a dinâmica do grupo foi escolher obras que se enquadrassem nesta categoria de clássicos, que fossem de menor extensão e acessíveis (podendo ser encontradas em páginas da rede, tal como o acervo disponível no “Domínio Público”). Almejamos, também, estimular as pessoas a ocuparem seu tempo livre com a literatura, fazendo disso um hobby. Para isso, foi necessário que os encontros fossem momentos gratificantes, agradáveis, sem a pressão sobre os participantes para que provassem o domínio sobre os gêneros literários e os autores escolhidos, mas sim, um momento ideal para promover a autoformação de todos, de maneira leve. Por certo, foi fulcral o desejo de fazer dos encontros coletivos um espaço potencial para a autoformação, tornando-o um momento de compartilhamento de saberes e conhecimentos, bem como de apropriação da cultura literária em geral. Portanto, nas reuniões, tentamos criar uma atmosfera bastante acolhedora e, uma vez não tendo nenhuma ambição acadêmica com o projeto, nosso interesse foi prosear sobre as obras, respeitando os bons costumes mineiros. Foram, ao todo, oito
encontros, com frequência quinzenal, durante os quais debatemos obras de diversos gêneros textuais, que estão elencadas abaixo:
- As crônicas: “O coitado do corpo...” e “O cemitério”, de Rubem Alves;
- Os contos: “A terceira margem do rio” e “Duelo”, de João Guimarães Rosa; “Sonho” e “As palavras da máquina”, de João do Rio; “O fantasma de Canterville”, de Oscar Wilde; e “O Alienista”, de Machado de Assis;
- Os poemas: “O Canto Geral” (cantos I, II, III e IV), de Pablo Neruda; e “Morte e Vida Severina”, de João Cabral de Melo Neto.
Ainda que fôssemos poucos nas reuniões, em torno de seis integrantes por encontro, tivemos a grata
surpresa de receber pessoas de outras localidades, fora de Teófilo Otoni, além de professores e estudantes de outros campi, como o caso do professor Alex Lara, do IFNMG/ Campus Pirapora e a aluna Isadora Cathalar, do IFNMG/Campus Almenara. Recebemos ainda membros externos do IFNMG, estudantes egressos do Campus Teófilo Otoni e professores que contribuíram, decisivamente, para a realização das atividades do projeto. Como comentou uma das integrantes do grupo, Nádia Bueno, em uma de nossas reuniões, “ler os clássicos é um ato de vontade”; por isso, mesmo que nos encontremos com um número reduzido de participantes neste
primeiro ciclo de ações do projeto, acreditamos que conseguimos despertar neles essa vontade, de modo singelo e humilde, ao longo de nossos encontros.
Agora, a pergunta “Por que ler os clássicos?” persiste. Ao invés de especular a relevância do projeto somente por meio do olhar de seu coordenador, deixemos as impressões dos próprios integrantes do grupo falarem por si, visto que a experiência é subjetiva, podendo conter sensações bastante particulares. É o caso da bolsista do projeto, Ana Júlia Teles, que afirma
que sua participação no Clube de Leitura foi “uma experiência muito boa. Me surpreendi com as obras propostas, a diversidade de cada uma me fez enxergar além. Estar em contato com esse tipo de obra foi surpreendente, cada autor com suas particularidades me apresentou concepções de mundo muito interessantes. E as reuniões são tão boas, é tão bom discutir e ver vários pontos de vista sobre um mesmo texto”. Ana Júlia tem razão, os clássicos sempre nos surpreendem, pois a sua leitura é sempre uma jornada de descobertas e, como

afirmou Calvino, “um clássico é um livro que nunca terminou de dizer aquilo que tinha para dizer” (2007, p. 11). Entretanto, o mesmo autor nos lembra que ler os clássicos pode ser formativo, e, sobre isso, a Isadora Cathalar afirma que, desde sua participação no projeto, leituras que ela não faria sozinha, como livros de poesia, passaram a fazer parte da sua rotina. E acrescenta que, “além disso, as discussões (nas reuniões) nos fazem ver a obra com um olhar mais crítico e subjetivo que nos permite interpretações mais profundas. A escolha dos li -
Contação - Aprende-se ensinando nos Vales e Gerais
vros ser coletiva é algo muito bom e a proposta do clube de títulos clássicos é muito enriquecedora principalmente para mim, pois estou na fase de realizar o vestibular”.
A bolsista Letícia Costa versa suas impressões nesse mesmo sentido que a Isadora e diz que “durante a execução do projeto tive a oportunidade de desenvolver novas técnicas de leitura e de apreciar a leitura de obras clássicas nacionais, principalmente as do autor Guimarães Rosa, que possui ,em seus contos, um vocabulário de fácil interpretação e que estimula nossa imaginação. Além disso, tal
experiência me auxiliou a resgatar a rotina de leitura que, há muito tempo, não tinha, e teve um papel significante em meus estudos de interpretação textual, pois os debates que fazíamos nos encontros estimulavam a interpretação pessoal de cada um, fazendo com que aprendêssemos a ler contos/ poemas e a estabelecer um paralelo com a vida real, com nosso cotidiano e a expor nossas impressões de forma crítica”. Se a leitura dos clássicos gera um processo formativo, isso apenas ocorre diante do fato de que o acesso à cultura é um direito social, como bem acentua

a integrante Nádia Bueno: “Obras clássicas da literatura são parte do patrimônio comum, logo, direito de todos. Participar do ‘Clube de Leitura’ é, para mim, uma forma de fazer valer o direito de acessar e me apropriar de valiosas criações humanas do universo da cultura escrita. E fazer isso coletivamente torna tudo mais prazeroso!” Nem sempre o que prospectamos para nossos projetos é estabelecido em sua execução; porém, cremos que os relatos dos participantes do grupo nos fornecem um indicativo da função do projeto para eles. Para alguns, aquilo que inicialmen -

te planejamos foi alcançado; para outros, o relato aponta para novos desejos que nem havíamos pensado. É forçoso dar acento a isso, pois tais apontamentos certamente serão úteis para reflexões futuras do projeto.
De todo modo, os integrantes do projeto acreditam que conseguiram alcançar aqueles objetivos principais, a saber: ler obras clássicas e que nossos encontros fossem momentos prazerosos e divertidos, assim como outros lazeres que escolhemos nas nossas vidas. Não
obstante, talvez, os relatos trazidos não sejam suficientes para revelar a importância do projeto, pois não parece convincente que um número sem fim de depoimentos irá aclarar, para o leitor desta “narrativa de experiência”, as consequências da leitura dos clássicos nas pessoas, nem mesmo nos esclarecer “Por que ler os clássicos?” A questão insiste em nos acompanhar. Porém, oxalá, tenhamos uma vida longa e, quem sabe, com mais alguns anos de projeto, cheguemos a uma resposta definitiva a essa pergunta (se
isso for possível!). Enquanto isso, estamos como o personagem de Guimarães Rosa, em “A terceira margem do rio”, que apela ao pai para embarcar na canoa com ele:
“— Pai, o senhor me leva junto, nessa canoa?” (1984, p. 56).
Nós já embarcamos nessa canoa e não sabemos se vamos encontrar uma margem firme para ancorar, ou se nos acompanhará, relutante, a ilusão de uma terceira margem; no entanto, seguimos navegando sobre o rio. Veremos para onde os clássicos nos levarão.
Contação - Aprende-se ensinando nos Vales e Gerais

Problematizar a desiguldade racial é uma forma de desnaturalizá-la, marcar sua historicidade e contribuir para sua necessária superação. Esse projeto foi pensado com o objetivo de criar um espaço de estudo e reflexão sobre as relações étnico-raciais e suas implicações na educação.

Oprojeto Grupo de Estudos Maria Firmina dos Reis: relações etnicorraciais e educação foi desenvolvido de forma virtual. Reuniu pessoas da comunidade escolar do IFNMG e comunidade externa, estudantes de graduação e pós-graduação, assistentes sociais, docentes do IFNMG e da rede estadual de MG. Desde 2003, com a promulgação da Lei 10.639/03 e, posteriormente, a Lei 11.645/08, tornou-se urgente a implementação de pesquisas e ações na educação para alterar a situação de desigualdade racial, que


estabelece um fosso social entre brancos e negros. Em 2008, a Lei 11.645/08 alterou a Lei 10.639/03, marcando a necessidade de se ensinar e aprender sobre a história e cultura dos povos indígenas e sua participação na construção do país. Assim, o projeto foi vinculado ao NEABI do IFNMG e nomeado Maria Firmina dos Reis, em homenagem à educadora negra e primeira mulher a escrever e publicar um romance no Brasil, no final do século XIX.
Começamos com o livro do pensador indígena Ailton Krenak, “Ideias para adiar o fim do mun -
do”,no qual o autor problematiza a forma como a humanidade é construída a partir de uma noção que exclui os povos tradicionais: estes são considerados como parte de uma sub-humanidade. Os povos tradicionais, conforme Krenak, são irmanados com a natureza, exemplifica com a forma como os rios, montanhas e outros elementos naturais são considerados como parentes. Na sequência, discutimos o livro da filósofa Djamila Ribeiro, “Quem tem medo do feminismo negro?,” que traz um conjunto de artigos, nos quais são discutidos temas e conceitos importantes
Contação - Aprende-se ensinando nos Vales e Gerais
para o feminismo negro, como emponderamento, interseccionalidade e racismo institucional.
Foram lidos, também, alguns capítulos do livro “Racismo recreativo”, do jurista Adilson Moreira, que discute a utilização do humor como meio de efetuar agressões racistas. O autor analisa, minuciosamente, sobre como o racismo se adequa às condições sociais de cada período histórico para se fazer mais efetivo na produção e manutenção de hierarquias entre brancos e negros.

O grupo também leu e discutiu o livro “Do silêncio do lar ao silêncio escolar”, da educadora Eliane Cava -
leiro. A autora adentrou uma escola de educação infantil da cidade de São Paulo, onde acompanhou o cotidiano escolar, e o livro apresenta os resultados da pesquisa. Percebeu formas silenciosas pelas quais o racismo se faz presente no cotidiano das crianças desde a mais tenra idade.
Também foi lido e debatido o livro “Tornar-se negro”, da psiquiatra Neusa Santos, no qual se discutem os dilemas dos negros e negras em ascensão social no Brasil. A autora entrevistou diversas pessoas e percebeu que negras e negros brasileiros em ascensão social são leva -
dos a se afastarem de sua história e cultura para serem aceitos nos espaços sociais tradicionalmente brancos, o que gera sofrimento psíquico.
Elencamos apenas alguns dos vários textos que foram discutidos durante o período de desenvolvimento do projeto. As reuniões ocorriam no período da noite, geralmente entre 18 e 21 horas. Ao fim de cada reunião, eram decididos, o texto, data e o horário do próximo encontro. Foram momentos de troca riquíssimos entre os participantes.

Coordenadora: Daiane Silva de Andrade
Discente bolsista: Lorena Mendes Barbosa
Colaboradores: Alex Sander Luiz Campos e Rosana de Jesus dos Santos
Autor do relato de extensão: Daiane Silva de Andrade Campus: Salinas Público-alvo: Comunidade em geral Período: 14/06/2021 a 14/12/2021

Écomum, finda a leitura de uma obra, a ânsia de algumas pessoas por trocar sensações com outros leitores. Foi desse desejo que nasceu o Clube de Leitura do IFNMG – Campus Salinas, com o objetivo de, por meio de encontros mensais em ambiente virtual, promover o letramento literário e colaborar com a formação de uma comunidade de leitores.
O clube passou a ter um perfil no Instagram, com informações sobre seu funcionamento, a obra escolhi-
Logomarca do Clube de Leitura IFNMG/Campus Salinas, criada para divulgação do projeto nas redes sociais

Campus Salinas: da leitura individual à construção de uma comunidade leitoraLorena Mendes Barbosa Lorena Mendes Barbosa
Material para divulgação do encontro do mês de novembro
da para leitura e discussão no mês e, também, um formulário para inscrição. Além disso, um grupo no WhatsApp foi criado para interação, divulgação de materiais e impressões iniciais sobre a leitura.
Os encontros foram realizados pela plataforma Google Meet e democratizaram a participação nas reuniões, pois pôde aproximar pessoas de espaços e realidades distintas. A cada encontro, tornou-se nítido o quanto ouvir as impressões alheias sobre uma obra e, também, ter es-
paço para expor sensações, dúvidas e reflexões se tornou um hábito que uniu o grupo, como pode ser observado no depoimento dos ex-alunos Luighi Ricardo Gonçalves de Souza e Sara Mendes Marques:
“Sem dúvidas, para nós é uma honra participar de um clube do livro, sempre foi um sonho, desde a infância. Ter com quem partilhar experiências literárias é fantástico. É uma alegria ter um espaço para falar sobre literatura, e tê-lo evidencia, para nós, a necessidade de mais ambientes como esse.”

Dessa forma, mais que experiências particulares de leitura, fomos criando a almejada comunidade de leitores, capaz de escolher a obra a ser analisada em cada mês e também de se reconhecer ou se distanciar de algumas ideias expostas no encontro. Foi instigante também notar a importância da atuação discente. A bolsista Lorena Mendes Barbosa, por exemplo, surpreendeu-se com a quantidade de assuntos discutidos num só encontro:
“O projeto foi uma das melhores



oportunidades que tive em 2021. O aprendizado que adquiri em organização das redes sociais, criação das artes e divulgação das informações me deixou cada vez mais apaixonada pelo trabalho feito. Aprendi sobre temas que, nos espaços que antes frequentava, não eram discutidos. São conhecimentos para a vida.”
Além dessa variedade de temas e olhares suscitados por uma obra, muito nos chamou a atenção o fato
de os encontros reunirem pessoas de perfis heterogêneos. Muitas pessoas passaram a enxergar o clube como possibilidade de manter um hábito diferente de suas práticas cotidianas, como fica explícito no relato da bióloga e atual diretora do Ensino Técnico do IFNMG – Campus Salinas, professora Sileimar Maria Lelis:
“Eu tive a honra e o prazer de participar de vários encontros remotos durante um período em que a pandemia
estava muito pronunciada e aquela horinha me fazia muito bem. Era encantadora a troca de experiências com as diversas pessoas do encontro, e, por várias vezes, me emocionei com os depoimentos das experiências que tiveram durante a leitura.”


Dessa forma, o clube de leitura cumpriu seu objetivo inicial de agregar pessoas em torno da leitura e tornar-se um espaço de partilha, exercício da alteridade e reflexão.


Discente bolsista: Flávio Lucrécio da Silva Borges e Saulo Esdras de Matos Carneiro
Colaboradoras: Elza Cristiny Carneiro Batista e Ana Amélia dos Santos Cordeiro Autor do relato de extensão: Francisco Valdevino Bezerra Neto
Campus: Arinos
Público-alvo: 500 estudantes da educação básica
Período: 14/06/2021 a 14/12/2021
As ações, deste perojeto, envolveram observação de aves, registros fotográficos, identificação e divulgação das espécies observadas, além da organização e distribuição gratuita de um catálogo que foi distribuído para bibliotecas de todas as escolas do município de Arinos e campi do IFNMG.
Oprojeto de extensão “Meu cerrado de asas e flores: observação e registro fotográfico no Campus Arinos” teve início em 2021, com o objetivo de registrar aves e flores na área do IFNMG/Campus Arinos e seu entorno.

Como resultados desse primeiro ano de execução, foram identificadas 105 espécies de aves na área do Campus e 211 espécies na área do município de Arinos. O projeto teve ainda outros desdobramentos além do esperado, como a identificação de 72 espécies no estado de Goiás
e 32 espécies no Distrito Federal. Tais registros hoje fazem parte dos dados das plataformas de ciência cidadã mais conhecidas e utilizadas no Brasil.
As aves identificadas na área do Campus Arinos compuseram um catálogo impresso e colorido de 33 páginas, que foi distribuído, gratuitamente, às bibliotecas de todas as escolas (públicas e privadas) do município de Arinos e a todos os campi do IFNMG.
O impacto desse primeiro ano de execução mostrou-se muito positivo, alcançando resultados que não prevíamos, como o grande número
de seguidores no Instagram e os depoimentos de pessoas impactadas pelo trabalho. Entre esses depoimentos, aparecem agradecimentos e relatos de moradores de Arinos que antes não percebiam a riqueza da biodiversidade da região e, depois de acompanharem a divulgação das ações do projeto e do catálogo, passaram a observar, com outros olhos e, também, a valorizar o ambiente em que sempre viveram.
Concomitantemente às ações de divulgação e conscientização sobre a preservação, a prática da observação de aves (birdwatching) tem sido
Contação - Aprende-se ensinando nos Vales e Gerais

divulgada e incentivada pelo projeto, que, no próximo ano, incluirá oficinas (ou passarinhadas) nos eventos do IFNMG/Campus Arinos. Associado ao registro das aves, o projeto também contempla o registro das flores nativas, mas a divulgação desta ação ocorrerá apenas na próxima edição do projeto.
Para o professor Francisco Bezerra, coordenador da proposta, “O incentivo à contemplação da natureza já é o grande diferencial
do projeto, mas é preciso ir além, e propiciar à comunidade o conhecimento de sua diversidade. É como essa ponte que o projeto atua, socializando o conhecimento sobre parte das riquezas do nosso cerrado e incentivando o interesse pela pesquisa e conservação”.
Durante o ano de 2022, a equipe pretende continuar as observações e registros para além da área do campus e incentivar o uso dos catálogos nas escolas, por meio de par-
cerias e projetos interdisciplinares. A participação da ciência cidadã, por meio da alimentação das plataformas Wikiaves e Ebird também continuarão, inclusive, com o incentivo à participação dos estudantes e da comunidade em geral neste trabalho. Hoje existe um grande vazio de dados sobre o Noroeste de Minas Gerais nas plataformas citadas e esse projeto pretende preencher esse espaço.
Contação - Aprende-se ensinando nos Vales e Gerais





Atividade desenvolvida pelos alunos sobre as aranhas

Coordenadora: Valéria Magro Octaviano Bernis
Discente bolsista: Luísa Cordeiro de Oliveira Discentes voluntários: Bethânia Silva Gil de Freitas, Camila Sousa Bitencourt, Éllen Araújo de Deus, Gabriela Azevedo da Silva, Gabriele Barbosa Penha, Joyce Costa Ribeiro, Maria Markolina Alves Durães, Maria Paula Machado Silva, Sandy Micaele Aquino Teixeira e Sani Keli Fernandes Moreira
Colaborador: Walter Octaviano Bernis Filho
Autor do relato de extensão: Valéria Magro Octaviano Bernis Campus: Salinas Público-alvo: Alunos do ensino fundamental
Período: 14/06/2021 a 14/12/2021
Animais sinantrópicos são aqueles que se adaptaram ao convívio com os humanos e podem transmitir zoonoses ou causar acidentes à saúde humana. Assim, este projeto possibilitou a conscientização da comunidade acerca da importância ecológica dos mesmos e sobre a prevenção de acidentes, causados por eles.
Luísa Cordeiro de OliveiraOs animais sinantrópicos são definidos como aqueles que se adaptaram a viver junto ao homem, a despeito da vontade deste, podendo ser peçonhentos ou não. No entanto, em sua maioria, ocasionam acidentes, como no caso dos escorpiões e cobras, ou são responsáveis pela transmissão de doenças, como os mosquitos, barbeiros e ratos. Neste sentido, o Projeto de Extensão Pragas Urbanas- Bichos S.A buscou promover, por meio de material didático e lúdico, a apresentação de conhecimentos específicos sobre o modo de vida desses animais, a importância destes para o ecossistema, a relação do seu aparecimento no meio urbano, tendo, como causa, por exemplo, o acúmulo de lixo. Visou também esclarecer maneiras de prevenir os acidentes que ocorrem com o contato com estes animais.

O público-alvo escolhido foram as crianças, devido à alta capacidade de absorção e disseminação do conhecimento, o que as tornam poderosas agentes de mudança no meio onde vivem. A discente voluntária do projeto, do Curso de Licenciatura em Ciências Biológicas, Gabriele Barbosa, relatou que “o
projeto Pragas Urbanas foi e continua sendo de suma importância. Por meio dele, conseguimos aprender e passar muitos conhecimentos. Ensinar para as crianças como funciona o ecossistema e a importância de certos animais para um bom funcionamento da vida é muito válido. Elas crescem já sabendo e transmitindo esses aprendizados, até mesmo, para a própria família que, em sua maioria, não tiveram acesso a esse tipo de informação. Além disso, quando recebemos o
retorno dos professores, mostrando algumas aplicações das aulas ministradas, é muito gratificante e nos fazem ver que estamos no caminho certo.”
O projeto teve início em julho de 2021, de forma remota, devido às limitações impostas pela pandemia da COVID-19, com a participação dos alunos do 3º, 4º e 5º anos do Ensino Fundamental da Escola Estadual Doutor João Porfírio, localizada no município de Salinas- MG. Os discentes do Curso bacharelado em

Medicina Veterinária, com os alunos do Curso de Licenciatura em Ciências Biológicas, sob a coordenação da professora do projeto, Valéria Magro Octaviano Bernis, elaboraram videoaulas sobre 11 animais sinantrópicos, sendo eles, aranhas, escorpiões, morcegos, sapos, cobras, pombos, barbeiros, ratos, saruês, lagartixas e mosquitos.
Os temas foram tratados por meio de linguagem simples e objetiva, contendo imagens e ilustrações, a fim estimular maior interesse e compreensão das crianças. Para a coordenadora do Projeto a professora Valéria Bernis: “As alunas que participaram do Projeto Pragas Urbanas – Bichos SA se tornaram também agentes transformadores da sociedade, uma vez que levam, à comunidade, os aprendizados adquiridos em seus cursos em formação, praticando a “troca de experiência” de forma interdisciplinar e entre cursos do IFNMG/Campus Salinas. Avalio também o desenvolvimento de práticas de oratória, técnicas de ensino e, também, para as alunas da Medicina Veterinária, o papel significativo do Núcleo de Apoio à Saúde Familiar (NASF), de grande importância na saúde públi-
ca, e uma das esferas de atuação no futuro exercício profissional.”
Após o envio de todas as videoaulas, foi disponibilizado, aos alunos, via plataforma digital, um questionário contendo perguntas relacionadas ao aprendizado transmitido ao longo do projeto, com intuito de avaliar o conhecimento adquirido. Pode-se perceber que, mesmo em tempos de pandemia, com o ensino sendo realizado a distância, o resultado foi satisfatório e as crianças se mostraram ativas e dispostas a realizar todas as atividades propostas pelas professoras sobre os temas das videoaulas. Foram confeccionadas dobraduras, produções de textos e, além disso, houve alunos que gravaram vídeos, reproduzindo o que foi ensinado pelo projeto.
A participação da coordenadora e professoras da Escola Estadual Doutor João Porfírio foi fundamental para o sucesso do projeto, haja vista que, desde o primeiro contato, mostraram-se dispostas a auxiliar na implementação desse e deram, à discente bolsista, todo o apoio necessário. Para a discente em Medicina Veterinária, bolsista do projeto, Luísa Cordeiro, participar do projeto foi um desafio que possibilitou uma
das experiências mais marcantes em sua vida acadêmica: “O projeto Pragas Urbanas- Bichos S.A me permitiu conhecer um novo campo de atuação da Medicina Veterinária e me apresentou a importância de levar conhecimento através de um público-alvo diferente de tudo que imaginei. Fiquei surpresa com a capacidade das crianças em aprender e, principalmente, em compartilhar o conhecimento.”
Esses fatos comprovam a importância do projeto para a sociedade, uma vez que as ações desenvolvidas geram a mudança de pensamentos e comportamentos nas crianças e, consequentemente, naqueles que convivem com elas. E assim finalizamos, com a opinião entusiasta de mais uma das voluntárias do projeto, a discente da Medicina Veterinária, Sani Kely Fernandes Moreira: “participar do projeto é sempre uma experiência incrível! É uma satisfação poder passar o nosso conhecimento para os alunos; essa interação é de grande importância, pois podemos compartilhar informações essenciais para prevenir e controlar os animais sinantrópicos em suas casas; além disso, poder ter essa troca com as crianças é sensacional.”
Contação - Aprende-se ensinando nos Vales e Gerais

Produção de texto orientada pelas professoras e realizada pelos alunos, com o tema escorpião e rato

Coordenadora: Suzana Alves Escobar
Discente voluntária: Lucilene Machado dos Santos

Autora do relato de extensão: Suzana Alves Escobar Campus: Salinas
Públicos-alvo: Servidores e docentes do IFNMG Período: 1103/2021 a 25/03/2021
“Mas
Apolítica de cotas implementada nos Institutos Federais, após a publicação da Lei 12.711/12, deve ser pensada para além de uma relação matemática entre número de vagas versus preenchimento, já que a educação tecnológica é especialmente vocacionada e impulsionada pela proposta de desenvolvimento integral do ser humano.
Foi nesse contexto que se pensou, durante a execução da pesquisa no Mestrado Profissional em
Educação Profissional e Tecnológica, no projeto de extensão denominado “Implementação das cotas raciais no IFNMG-Campus Salinas: discutindo a (in)visibilidade dos alunos cotistas raciais”. O minicurso foi realizado em três encontros virtuais, no período de 11 a 25 de março de 2021, por meio do Google Meet, tendo em vista o contexto da pandemia da COVID-19.
A invisibilidade do cotista foi apontada em diversos relatos de participantes durante o minicurso. Essa invisibilidade social do negro,
do indígena e de outros grupos é refletida também no ambiente institucional, que, após o ingresso do aluno pelo sistema de reserva de vagas, não lhe garante mecanismos de escuta e nega sua alteridade. Essa ausência foi nomeada por um dos participantes como “poder de fala”.
Esse poder de fala decorre da experiência e vivência dos sujeitos e deveria ser ocupado por aquele que, efetivamente, vive o que se reproduz. Entretanto, o poder de fala, ou, ainda, o poder da palavra
Contação - Aprende-se ensinando nos Vales e Gerais
discutindo a (in)visibilidade dos alunos cotistas raciais
continuam sendo exercidos pela mesma classe política e econômica que predominava na colonização. No decorrer do minicurso, diversos relatos trataram da necessidade de ruptura desse status.
Relatos de ausência de escuta, invisibilidade e entristecimento dos cotistas foram frequentes. Há um silenciamento sufocante e esmagador que precisa ser reconhecido e ultrapassado. Como bem ponderou uma dos participantes, “(...) nós precisamos de som, nós precisamos de tambores. De esses alunos emitirem o som que está engasgado”. (Relatório de Campo, 28/03/2021).

Esses alunos suportam, muitas vezes, a solidão do banquinho da praça escolar, a dificuldade de compreensão do livro na biblioteca, do exercício do professor e a impossibilidade e vergonha de pedir ajuda. É um caminho solitário e injusto. Isso porque, conforme foi se comprovando durante o transcorrer do minicurso, a inserção no ambiente educacional pelo sistema de cotas não garante, por si só, que os cotistas tenham voz e vez no espaço institucional. Tanto é assim que, nem mesmo, há um conhecimento sobre a trajetória, experiência e vivência daqueles que ingressam por esse sistema.

O projeto de extensão demonstrou que as instituições federais de ensino, ao cumprirem a reserva de vagas imposta pela Lei 12.711/12, possuem a responsabilidade de pensar políticas internas para tra -
tar das questões étnico-raciais, contribuindo com a ruptura dessa cultura do silenciamento e invisibilidade dos cotistas. Embora essa não seja essa uma tarefa fácil, estamos convencidas de que é


plenamente possível, desde que pautada por um esforço coletivo e sincero para construção de uma instituição mais inclusiva, justa e democrática, onde se garanta voz e vez aos cotistas.
-
Coordenadora: Ana Lúcia Ferreira Oliveira de Freitas
Discente bolsista: Isabella Cristina Alves Ferreira
Discentes voluntárias: Talita Adrielly Pereira Brandão e Edilayne Basil da Cruz
Colaboradores: Valdinice Ferreira da Mota e Jean Carlo Laughton de Sousa
Autora do relato de extensão: Ana Lúcia Ferreira Oliveira de Freitas Campus: Arinos
Público-alvo: Discentes e egressos do IFNMG- Campus Arinos Período: 01/10/2021 a 31/03/2022
O projeto buscou realizar o acompanhamento dos egressos do IFNMG- Campus Arinos com o intuito de efetuar a mediação, recolher e disponibilizar informações para identificar as experiências profissionais que configuram as trajetórias dos egressos da instituição.
Aprimeira motivação para realização do acompanhamento dos egressos do IFNMG, pela Extensão, é a responsabilidade institucional da Pró-Reitoria de Extensão e Cultura (PROEXC) em realizar a mediação, recolher e disponibilizar informações para identificar as experiências profissionais que configuram as trajetórias deste público. Sobretudo, investigar como eles estão inseridos no mundo do trabalho e quais as práticas educativas relevantes para a formação deles como profissionais. Também nos encorajou, para a realização do projeto, a necessidade de avaliar a situação dos egressos no mundo do trabalho, auxiliando no planejamento, definição e retroali-
mentação das políticas educacionais do IFNMG em nível mais específico, podendo contribuir para uma redefinição didática, curricular e avaliativa do Projeto Pedagógico dos Cursos do Campus Arinos.
No total, foram envolvidas na pesquisa, aproximadamente, 735 pessoas, entre a equipe do projeto formada por docentes, acadêmicas do Curso de Bacharelado em Administração e técnicos administrativos. Todos eles contribuíram com informações sobre os egressos do campus, do ano de 2019 ao primeiro semestre de 2020 e pré-egressos.
Segundo o relato da coordenadora Ana Lúcia, “nosso grande desafio estava em desenvolvermos o projeto totalmente de forma não presencial,
por ainda estarmos em um momento pandêmico, conseguir envolver tantas pessoas sem estar no ambiente acadêmico e sem ter o contato físico”. Nesse sentido, teve-se a ideia da criação de um Instagram do projeto, no qual seriam divulgadas informações acerca da importância deste e da necessidade de respostas dos egressos e pré-egressos. De posse das listas enviadas pelas secretarias do campus, foram enviados convites para a sensibilização e participação de todos por meio das redes sociais. Após a sensibilização, foram desenvolvidos dois questionários eletrônicos na plataforma do Google Forms, um destinado para aos egressos e outro aos pré-egressos do campus e enviados a esses via WhatsApp.

Reunião para elaboração Relatório Final

O questionário eletrônico foi enviado para 133 pré-egressos, Desses, somente 17 responderam. Com relação ao perfil dos respondentes, 64,7% eram do sexo masculino e 35,3% do sexo feminino; a maioria (58,8%) com idade entre 15 a 20 anos e pardos (64,7%). Pôde-se observar que a maioria (70,8%) não é natural de Arinos e possui a pretensão de mudar de cidade após a conclusão do curso (52,9%). Apenas 17,6% declararam que ainda não se decidiram sobre essa questão. Sobre os cursos, um percentual de 35,3% pertencia ao Curso Técnico Integrado em Agropecuária, seguido dos Cursos Técnico Integrado em Informática (23,5%), Tecnologia em Produção de Grãos (23,5%), Bacharelado em Administração (11,8%) e Tecnologia em Gestão Ambiental (5,9%). Apesar das diversas tentativas, não obtivemos respostas dos pré-egressos dos demais cursos do campus.
Ao serem questionados porque escolheram estudar no IFNMG/Cam-

pus Arinos, a grande maioria (76,5%) respondeu que a sua escolha se deu por ser uma instituição pública e de qualidade. E, se indicariam a instituição e o curso que estão fazendo para alguém, todos (100%) responderam que sim. A maioria (76,5%) também reconhece que o conhecimento adquirido no curso está ajudando na vida pessoal/ profissional e 68,8% expressaram que o curso atendeu suas expectativas, enquanto 35.3% responderam que o curso atendeu parcialmente suas expectativas.
Questionados se sentem preparados para atuar na área do seu curso, 58,8% disseram que não, 29.4% se sentem preparados e 11,8% já estão atuando na área. Dos que não se sentem preparados, 35,3% acrescentam que irão se especializar. Indagados sobre os estágios, 82,4% não estavam fazendo estágio e todos aqueles que responderam que sim avaliaram que o estágio contribuiu para a sua formação.
Sobre o mercado de trabalho,
76,5% responderam que não estão trabalhando por conta da dedicação exclusiva a atividades acadêmicas, 53,8% alegaram falta de oportunidade de trabalho na sua cidade, 15,4% alegaram não estarem trabalhando por exigência de experiência ou outro motivo. A margem salarial é de um a dois salários mínimos e estão, parcialmente, satisfeitos com seus empregos.
Na avaliação pessoal dos respondentes, estes consideram que foram bons alunos (64,7%), que tiveram um bom desempenho ao longo do curso (58,8%) e nunca ficaram em dependência (58,8%). Desejam manter contato com a instituição (70,6%) e o objetivo principal, após a conclusão do curso, é fazer graduação. Por último, como as atividades estavam sendo realizadas no formato ANP, em virtude da pandemia provocada pelo novo coronavírus (Covid-19), foi questionado se isso interferiu, de alguma forma, no desempenho durante o curso: 70,6% responderam que sim,
seguido de 17,6% que disseram ter interferido de forma parcial. Alguns pontos citados pelos alunos, que levaram a esse impacto no desempenho por conta da Covid-19, foram: impacto emocional, dificuldade no processo de aprendizagem, defasagem em algumas matérias, a falta de contato direto com os professores e com o ambiente escolar, falta de disciplina e organização nos estudos, ausência de aulas práticas, falta de foco durante as aulas remotas, entre outros pontos.
Quanto ao questionário eletrônico disponibilizado para os egressos, obtivemos 57 respostas de ex-alunos do Campus Arinos, com o seguinte perfil: 82,5% dos respondentes têm até 20 anos, 17,5% entre 21 a 30 anos. A maioria (57,9%) é do sexo feminino e se autodeclarou parda (56,1%). A maioria (82,5%) reside em Minas Gerais e 10,5% residem em Goiás. 78,9% são egressos dos cursos técnicos integrados ao Ensino Médio e 15,8% fizeram curso superior na instituição. Desses, 47,4% concluíram seus respectivos cursos no ano de 2019, 35,1% finalizaram em 2021 e 15,8% concluíram no ano de 2020.

Ao serem indagados sobre o mercado de trabalho, 63,2% não esta-
Contação - Aprende-se ensinando nos Vales e Gerais

vam trabalhando no momento, por conta de estarem dedicando, exclusivamente, às atividades acadêmicas, 16,7%, por falta de oportunidade na cidade onde moram. Dos que estavam trabalhando, a maioria (52,4%) atuava na sua área de formação e recebia entre um a três salários mínimos (71,4%).
Quando questionados se estavam satisfeitos com seus empregos, 47,6% responderam estar parcialmente satisfeitos e 42,9% totalmente satisfeitos. A grande maioria dos ex-alunos que responderam ao questionário afirmaram que o curso foi de suma importância para procurar outro emprego, ingressar ou manter-se no mercado de trabalho.
Na avaliação da instituição, 64,9% dos respondentes alegaram que o conhecimento adquirido no curso está ajudando na sua vida pessoal/ profissional e todos indicariam o
campus a alguém. Os principais pontos destacados para essa indicação foram a qualidade dos professores, as aulas práticas, as bolsas e incentivos, as viagens técnicas e a infraestrutura.

Por último, foi questionado se a pandemia provocada pelo novo coronavírus (Covid-19) repercutiu no ingresso no mundo de trabalho: 40,4% responderam que sim, 38,6% que não e 21,1% responderam que impactou parcialmente. O atraso na conclusão do curso, a falta de oportunidades, a defasagem no aprendizado, as dificuldades com o ensino on-line, o isolamento social e o fechamento de empresas foram alguns pontos citados pelos egressos como decorrentes da pandemia, que repercutiram em sua entrada no mercado de trabalho.
Contudo, mesmo diante de todas as dificuldades, o projeto foi realizado e atendeu seu objetivo de fazer o acompanhamento dos egressos e
pré-egressos, escutá-los nas suas ansiedades e dificuldades encontradas após o término dos seus estudos e suas impressões acerca dos cursos e da instituição. Tornar públicas essas informações preciosas adquiridas é importante, na medida que podem ser utilizadas no planejamento da instituição. Finalizamos com a fala da acadêmica Talita, voluntária do projeto, que sintetiza a importância da realização de projetos de extensão como esse: “participar do projeto de extensão Acompanhamento de Egressos foi uma experiência incrível, uma oportunidade para transmitir um pouco dos meus conhecimentos e adquirir muitos outros. Na minha opinião, é um projeto fundamental para acompanhar as expectativas dos alunos com relação ao curso, delinear o perfil do profissional formado e avaliar a sua inserção como egresso no mundo do trabalho”.
Coordenadora: Juliana Teixeira Antunes Discentes bolsistas: Vitória Salustiano de Souza e Pamella Carolina Tavares Silva Campus: Januária Público-alvo: Docentes e discentes do IFNMG - Campus Januária, discentes de instituições de cursos de especialização ou pós graduação e comunidade em geral Autora do Relato de Extensão: Juliana Teixeira Antunes Período: 23/06/2021 a 14/12/2021

Aadolescência é uma fase cheia de mudanças, aventuras e descobrimentos. Na saúde, é uma fase de vida marcada por modificações físicas e mentais dos indivíduos, o que requer grande atenção dos pais, professores e profissionais da saúde. Hoje, a Organização Mundial de Saúde (OMS) a considera como uma fase de grande vulnerabilidade a diversos fatores de risco, como uso de drogas, violência, transtornos mentais, inatividade física, problemas com a alimentação, sexualidade, enfim, riscos que podem ser evitados por meio da informação. Assim, o projeto “Saúde do adolescente e os desafios de uma nova geração” contou com a colaboração de diversos profissionais da área da saúde, direito e educação, para informar a comunidade sobre os desafios enfrentados pelos adolescentes e orientar as medidas de superação desses desafios.
Por meio da criação do perfil “projetoadolescentesaude” na rede social Instagram, foram divulgados diversos posts com informações relacionadas à saúde dos adolescentes e promoções de brindes e lives, com a participação de mestres em Ciências da Saúde, em Engenharia Elétrica, além do promotor de justiça, sobre temas como: comunicação, cyberbullying e violência.
Além das lives e post publicados no perfil “projetoadolescentesaude” e no canal do Youtube do IFNMG/Campus Januária, o projeto “Saúde do adolescente e os desafios de uma nova geração” promoveu um seminário, com o encontro de diversos palestrantes nas áreas de sociologia, artes, psicologia, psicopedagogia, enfermagem, nutrição e filosofia, trazendo temas como:

- adolescência, tempo e memória;
- comportamento do adolescente: o que é e não é normal;
- o adolescente e sua relação com a escola e amigos;
- representações sociais dos adolescentes sobre a sexualidade nas mídias sociais virtuais;
- associação entre consumo e hábitos alimentares com a ansiedade
e a depressão em adolescentes;
- como adolescer o pensamento para ser mais empático com os jovens.
O seminário aconteceu de forma online com transmissão, ao vivo, pelo canal do Youtube do IFNMG/ Campus Januária. Durante o evento, tivemos falas, como:
“Estamos vivendo tempos muito marcados por dois fatores: a veloci-
dade, essa sensação de que o tempo está acelerado [...] e um excesso de estímulos [...]. Se, na adolescência, uma das características mais importantes é o fato de a gente, justamente, precisar elaborar uma chuva de questões, é um momento de ruptura significativa com os ideais dados pela família, pais e de construção de novas perspectivas de apropriação [...], seu tempo de criação de sentidos e memórias cada vez mais diminuídos pelas demandas da velocidade e do imediatismo [...], gerando sentimentos de vazios de sentido, sentimentos de inexistência [...] e uma grande necessidade de validação que vem do outro.”(Renée Maia, doutora em Memória Social)
“É errado dizer aborrecência![...] A adolescência hoje, segundo a Organização Mundial da Saúde, vai até, aproximadamente, os 24, 25 anos de idade. Os adolescentes esquecem coisas[...], os adolescentes não têm
muita paciência para ficarem ouvindo sermões [... ], os pais precisam ter uma certa criatividade para se comunicarem com o adolescente de uma maneira mais lúdica, mais leve, menos rançosa. Isso vai trazer leveza para o relacionamento familiar. [...]” (Sônia Portes, escritora, mestre em Psicologia)
“Para os adolescentes, a sexualidade nas mídias sociais virtuais faz parte do seu cotidiano, tanto pelo consumo quanto pela autoprodução de conteúdos sexuais. Essas mídias virtuais influenciam a construção da identidade dos adolescentes e de sua sexualidade, incluindo relacionamentos afetivos e comportamentos sexuais de risco”. (Gabriela Prado, enfermeira, educadora em Saúde Sexual de adolescentes)
“Para o adolescente, amizade significa criar laços entre as pessoas que têm sentimentos de lealdade, proteção, intimidade, reciprocidade, ajuda
mútua, compreensão e confiança [...]. As relações com os amigos nessa fase constituem um dos principais fatores para a construção da identidade e para a definição de valores, ideias e opiniões sobre os outros e o mundo”. (Márcia Zakur Ayres, psicopedagoga, mestre em Promoção da Saúde)
“A geração Z, primeira geração nascida dentro de um mundo online e móvel. Depressão e ansiedade generalizada são duas das mais comuns preocupações em saúde mental na juventude [...]. Hábitos e comportamentos podem diminuir as chances de depressão e ansiedade: refeição em família e com alimentos saudáveis, limitar o tempo de tela a 3 h/dia, dormir por tempo adequado (8 a 10h/dia) e praticar atividades físicas. O Brasil tem o melhor guia nutricional do mundo!”. ( Lúcia Helena Almeida Gratão, nutricionista e mestre em Ciências da Saúde)


“Adolescer o pensamento perpas-
Contação - Aprende-se ensinando nos
sa pelo ato de amar, que é muito mais do que um sentimento: é um verbo, uma ação, de quem acolhe, educa e orienta para a vida.”(Juliana Micheletti, mestre em Gestão Social, Educação e Desenvolvimento Regional)
O seminário contou com a inscrição de 103 participantes, entre estudantes, professores e comunidade em geral, que receberam seus certificados de participação no evento. As palestras e lives foram gravadas e estão disponíveis nas redes sociais do IFNMG/Campus Januária, contando, até o momento, com, aproximadamente, 673 visualizações.

O projeto permitiu uma aproximação da comunidade acadêmica com especialistas e estudiosos da área de saúde do adolescente e trouxe informações sobre temáticas importantes para essa fase de vida. Além disso, contribuiu para a inserção de alunos do Curso Técnico de Enfermagem no universo da adolescência e na elaboração e divulgação de eventos científicos, despertando-os para a importância da divulgação de informações sobre saúde à comunidade. Podemos perceber, pelas falas abaixo, que o projeto permitiu uma maior compreensão da saúde do adolescente pelas alunas participantes.
“O projeto foi de extrema importância, tanto no quesito pessoal como profissional, pois através dele aprendi muitas coisas sobre os adolescentes, tais como seu desenvolvimento físico e emocional, a importância de uma boa alimentação e a prática de exercícios físicos, os benefícios de uma boa relação com os familiares e os amigos. [...] tive a oportunidade de passar todos esses assuntos para o público através de postagens feitas no Instagram e através de lives, que foram realizadas no YouTube”. (Vitória Salustiano de Souza, bolsista)
“O projeto saúde do adolescente foi de grande importância para o
meu desenvolvimento, tanto pessoal como profissional [...] creio que todos que participaram e que conferiram as lives e seguiram a página do projeto estão satisfeitos com todo o conteúdo disponibilizado, pois serviram de alerta e de ensinamentos, tanto para os adolescentes quanto para os pais. As pesquisas, os assuntos selecionados e pesquisados com todo carinho me fizeram compreender melhor a vida do adolescente e suas transformações [...]” (Pamella Carolina Tavares Silva, bolsista).
Diante das falas apresentadas,
percebemos a importância de se falar sobre saúde e, principalmente, a dos adolescentes. O projeto “Saúde do adolescente e os desafios de uma nova geração” oportunizou momentos para a reflexão sobre a saúde desses jovens, imersos em um cotidiano cheio de novidades e desafios. Espera-se que seja um primeiro passo para o despertar de novas propostas voltadas para a saúde dos adolescentes, uma fase de vida esquecida pelas políticas públicas.
Coordenador: Cleber Roberto Souza
Discentes voluntárias: Cláudia Leolina de Paula e Nathalia Souza Silva Colaboradores: Anamaria Azevedo Lafeta Rabelo e Tarso Guilherme Macedo Pires
Autor do relato de extensão: Cleber Roberto Souza Campus: Janaúba Público-alvo: Microempreendedores, trabalhadores e comunidade em geral Período: 01/06/2021 a 01/10/2021
Souza

ratidão por nos dar a oportunidade de crescer” (Vera Lúcia, aluna do projeto). Esta é a frase que traduz nosso projeto: Dar a oportunidade de crescer. Quando iniciamos nossa busca por parceiros, em maio de 2021, com o objetivo de estreitarmos laços com a comunidade por meio do nosso Núcleo de Administração, encontramos, na Sala Mineira do Empreendedor, o parceiro perfei-

to. Já na primeira visita, o então diretor Auredson Romeu Araujo da Silva, da Diretoria de Indústria, Comércio, Serviços e Turismo, da Prefeitura Municipal de Janaúba, perguntou-nos: “Quando vocês podem começar?”.
A partir deste ponto, começamos a pensar e a escrever o projeto de Extensão: Capacitação que Transforma, que levaria cursos de curta duração para um público escolhido pelo nosso parceiro. Focado, principalmente, em microempreendedores, mas

sem deixar de fora outras pessoas interessadas em se capacitar, montamos nosso projeto para oferecer capacitação em dois cursos para este público: Empreendedorismo I e Ferramentas de Estratégicas para Pequenos Negócios, cada um com 40 vagas inicialmente.
No curso de Empreendedorismo I, buscamos trabalhar questões que despertassem o interesse e mostrassem a importância dos empreendedores para nossa região. Mesmo em
um ambiente 100% digital, buscamos estimular os alunos com muitas atividades práticas e não apenas com as tradicionais aulas expositivas, e também escolhemos temas que trouxessem a aplicação imediata dos conhecimentos adquiridos, como podemos observar no relato do aluno Alan Marques (Empreendedorismo I):

“As atividades, os debates e as explicações me fizeram ter mais curiosidade acerca de empreendedorismo, tive muitas ideias a partir do curso, fiquei
supermotivado em iniciar um negócio próprio”.
Já no curso de Ferramentas de Estratégicas para Pequenos Negócios, trabalhamos várias ferramentas, como: Missão, Visão e Valores, 5 Forças de Porter, 5W2H, Metas SMART e Matriz SWOT, todas elas úteis para avaliar a empresa, seu mercado e seus concorrentes. Mesmo em temas mais técnicos, recebemos feedbacks positivos sobre quão práticos, úteis e atuais os cursos estavam sendo, como percebemos no relato da alu-
na Márcia Cavalcanti (Ferramentas Estratégicas):
“Na semana em que estávamos finalizando as aulas, o meu esposo, que estava participando de um processo seletivo de recrutamento, chegou em casa com uma análise SWOT que uma das candidatas para vaga fez. Eu achei incrível e já dá para perceber como o mercado de trabalho tem inserido estas ferramentas.”
Dentre as 80 vagas do projeto, tivemos 45 pessoas capacitadas, sendo 25 alunos certificados no curso
Contação - Aprende-se ensinando nos Vales e Gerais

Empreendedorismo I e 20 alunos certificados no curso Ferramentas Estratégicas para Pequenos Negócios. Nossos alunos tinham entre 17 e 53 anos, sendo 71% mulheres e 29% homens, com, no mínimo, o Ensino Fundamental Incompleto.

Sabemos que não é fácil executar projetos em tempos de pandemia e distanciamento social. São vários pontos que atrapalham, como a difi-

culdade de conciliar os estudos com as responsabilidades de casa, a falta de um ambiente adequado para os estudos, a falta de habilidades com as ferramentas digitais ou a limitação dos equipamentos ou internet. Ainda assim, fizemos o possível para levar um conteúdo relevante e de fácil entendimento.
Além da avaliação positiva dos alunos, o coordenador, prof. Cleber
Souza, avaliou o projeto com retorno positivo, pois, além do objetivo de capacitar pessoas, conseguiu-se levar o nome do Instituto Federal para pessoas que não o conheciam. Espera-se poder lançar novas versões do projeto nos anos seguintes, buscando aumentar a oferta de capacitação e o número de vagas, consolidando ainda mais a importância do projeto.
Coordenadora: Vanessa Gomes de Castro Discentes bolsistas: Amanda Saúde Pereira e Lucineide Pereira dos Santos Colaboradora: Lillian Gonçalves de Melo
Autora do relato de extensão: Vanessa Gomes de Castro Campus: Araçuaí Público-alvo: Juventude interna e externa ao IFNMG/Araçuaí Período: 01/08/2021 a 12/12/2021
O “Expressa juventude: identidades e narrativas plurais” permitiu o diálogo entre jovens internos e externos ao IFNMG/Araçuaí, por meio da realização de rodas de conversa e oficinas de comunicação audiovisual e escrita, abordando temas como pertencimento étnico-racial, direitos humanos, equidade e respeito à diversidade.

Oficina de Grafismos Indígenas.

Entre os meses de agosto a dezembro de 2021, foi desenvolvido o projeto de extensão “Expressa juventude: identidades e narrativas plurais”. O projeto teve, como objetivo geral, a realização de rodas de conversa e oficinas de comunicação audiovisual e escrita, por meio de vídeo, fotografia, rádio, fanzine e grafismos, abordando temas como pertencimento étnico-racial, direitos humanos, equidade e respeito à diversidade. Esse projeto foi realizado no âmbito no Núcleo de Estudos, Pesquisas e Extensão Afro-brasileiros e Indígenas (NEABI/IFNMG/ Araçuaí) e teve anuência expressa da comunidade e o apoio da Coquivale – Comissão das Comunidades Quilombolas do Vale do Jequitinhonha. O projeto foi desenvolvido no IFNMG/Campus Araçuaí e contou com a participação de duas professoras e duas alunas bolsistas.
Assim, foram realizadas cinco atividades no âmbito do projeto. A primeira foi uma oficina de “Grafismos Indígenas’’, conduzida por Tita Maxakali, que é cacique dos Canoeiros Maxakali. Essa oficina abordou pontos como: 1) O que é grafismo
indígena; 2) O que o grafismo representa para os povos indígenas; 3) Exemplos de grafismos de alguns dos mais de 300 povos indígenas do Brasil; 4) Tintas e utensílios utilizados para fazer os grafismos. Essa oficina aconteceu no dia 11 de setembro de 2021 e contou com a participação de 29 pessoas, entre alunos do IFNMG e comunidade externa. Destaca-se que essa atividade foi muito importante, uma vez que a região conta com várias aldeias e diversas etnias, e o IFNMG recebe muitos alunos indígenas. Logo, torna-se importante fortalecer os povos indígenas, suas culturas e suas lutas, sendo necessários mais espaços de visibilidade dentro da instituição, acolhimento aos estudantes e diálogo com a comunidade interna e externa.
A segunda oficina e roda de conversa desse projeto de extensão aconteceram no dia 2 de outubro de 2021. O tema foi “Podcast’’ e contou com a participação de 20 pessoas, entre alunos do IFNMG e comunidade. A proposta da oficina foi proporcionar um contato inicial com o mundo dos podcasts, um produto de comunicação que tem feito bastante sucesso nos últimos anos, es-
pecialmente entre as gerações mais jovens. O podcast é um conteúdo em áudio, disponibilizado por um arquivo ou streaming. Conta com a vantagem de ser produzido e executado sob demanda, ou seja, quando a pessoa quiser e sobre o tema que preferir. Os temas de um podcast são muito amplos: cinema, literatura, política, games, religião, humor, música, esporte, etc. Ressalta-se que esse tipo de oficina pode ser interessante para a juventude, uma vez que o IFNMG conta com diversas iniciativas de produção de podcast, várias envolvendo os próprios alunos. Essa oficina foi ministrada por Bruno Vieira, que é jornalista, com formação pela Universidade Federal de Minas Gerais (UFMG) e mestre em Psicologia, também pela UFMG.
No dia 23 de outubro de 2021, aconteceram a terceira oficina e roda de conversa deste projeto de extensão. O tema foi “A arte da Fotografia” e contou com a participação de 40 pessoas, entre alunos do IFNMG e comunidade. Os alunos e professores da Escola Estadual Industrial São José, do município de Araçuaí, foram os convidados especiais para essa oficina, que foi ministrada pelo pro -
fessor Ernani Calazans – artista plástico, mestre em Artes pela UFMG, pesquisador da cultura e costumes do Vale do Jequitinhonha, fotógrafo e professor titular de Arte no IFNMG/ Campus Araçuaí. Pontua-se que essa atividade proporcionou maior diálogo com a comunidade externa, sobretudo, com outra instituição pública de ensino, mostrando a importância dos projetos de extensão.
No dia 4 de dezembro de 2021, houve a quarta oficina e roda de conversa . A oficina contou com a participação de 20 pessoas, entre alunos do IFNMG e comunidade. O tema foi “Fazedores de arte: literatura e produção artesanal no Vale do Jequitinhonha”. Foi ministrada por Herena Barcelos, que é nutricionista, mestranda em Estudos Rurais, agente cultural, sertaneja de Itinga, no semiárido mineiro e escritora. Durante

a oficina, Herena apresentou um conteúdo riquíssimo sobre a produção de livros artesanais no Vale do Jequitinhonha, deu várias dicas sobre materiais reutilizáveis e ensinou a fazer dobraduras, mostrando as várias possibilidades de confecção artesanal de livros.
No dia 15 de dezembro de 2021, deu-se a última atividade desse projeto de extensão, que consistiu em uma roda de conversa organizada e conduzida, brilhantemente, por duas discentes e bolsistas do projeto: Amanda Saúde Pereira e Lucineide Pereira dos Santos, que está cursando o 2° período do Curso Superior de Administração no IFNMG/Campus Araçuaí. Amanda é moradora da Comunidade Quilombola Santo Isidoro; já Lucineide é moradora da Comunidade Quilombola de Lagoinha. O tema desta roda de conversa
foi: “Os efeitos do racismo na autoestima da mulher negra”. Ressalta-se que essa atividade foi importante e necessária, contando com a participação de várias mulheres negras, alunas e não alunas do instituto, que se sentiram tocadas por essa pauta, reforçando a importância das ações antirracistas, da representatividade e de espaços para o diálogo e acolhimento.
Assim, foram realizadas oficinas e rodas de conversa em âmbito remoto, voltadas às juventudes, visando abordar temas atuais e pertinentes. Observa-se que mobilizar as juventudes não é tarefa fácil, porém é importante e necessário. De acordo com a discente Amanda Saúde Pereira, participar deste projeto foi uma experiência muito satisfatória, pois foram debatidos vários temas de extrema relevância acerca da
Contação - Aprende-se ensinando nos Vales e Gerais
Oficina de Podcast.


Conversa: “Os efeitos do racismo na autoestima da mulher negra”.
história dos grafismos, podcast, literatura artesanal, entre outros. Nas palavras de Amanda: “participar das oficinas me proporcionou conhecimentos que levarei por toda a vida, além de me ajudar a quebrar um enorme paradigma ligado à comunicação social por meio das plataformas digitais”.
Já a discente Lucineide Pereira dos Santos ressalta que participar do projeto foi uma experiência incrível. De acordo com Lucineide: “A cada oficina realizada, pude conhecer e aprender conteúdos de grande importância, em um viés relacionado a causas sociais e contemporâneas. O projeto possui inúmeros pontos positivos, principalmente na perspectiva voltada para a mobilização dos jovens em busca da valorização da diversidade e aprimoramento da noção de identidade. Ficar responsável pela organização da última oficina se mostrou como um desafio em primeira instância. No entanto, no decorrer do desenvolvimento da atividade, foram superados obstáculos e finalizamos com chave de ouro.
Que venham mais oportunidades como essa, para juntos fazermos a diferença e lutarmos por uma sociedade justa”.
Para a professora Lillian Gonçalves de Melo: “O projeto de extensão Expressa Juventude: identidades e narrativas plurais foi uma experiência muito exitosa por meio de oficinas/ roda de conversa, que possibilitaram interagir com saberes e identidades plurais. Na oficina de grafismo, aprendi sobre a cultura indígena; na de podcast, o foco foi a comunicação virtual, tão importante neste período de isolamento social; a oficina de fotografia mostrou o quanto há detalhes da vida e dos objetos que podemos registrar e partilhar; na de literatura, o foco foi o fazer literário como representação da própria existência humana; e, por fim, a roda de conversa sobre os efeitos do racismo na autoestima da mulher negra mostrou a violência, ainda existente no contexto hodierno e a força da mulher negra em não aceitar mais essa condição. Durante todas as oficinas, foram vários os diálogos e, principal-

mente, reflexões impulsionadas pela juventude, enfatizando, ainda mais, a necessidade da promoção desses saberes. Espero que este projeto continue, pois é de suma importância, principalmente, pelo seu caráter formativo e reflexivo”.
Considerando todas as atividades do projeto, contabilizou-se a participação de, aproximadamente, 125 pessoas, entre alunos e comunidade, desde pessoas da região, pessoas de cidades mais distantes e, até mesmo, de outros estados – um ponto positivo de as atividades serem remotas. As oficinas e rodas de conversa foram conduzidas por convidados qualificados e conhecidos na região. Acredita-se que o projeto cumpriu suas metas e seus objetivos, de valorizar a juventude, a diversidade, a construção de narrativas pessoais e coletivas, o reconhecimento e a autoafirmação étnico-racial, utilizando recursos audiovisuais e plataformas digitais, estimulando a participação dos discentes e favorecendo o engajamento extensionista no desenvolvimento de ações.
Contação - Aprende-se ensinando nos Vales e Gerais
Foto das oficinas.

Oficina Literatura e produção artesanal.

Considerando a função social do IFNMG Campus Montes Claros e objetivando o desenvolvimento regional e local, foram selecionados alunos dos bairros no entorno do campus, do nono ano do fundamental, para serem preparados para fazerem a prova de ingresso para qualquer curso do EMI.

Oprojeto teve, como objetivo principal, colaborar com a construção da formação educacional dos discentes da Escola Municipal João Valle Maurício, Escola Municipal Rozenda Zane Morais e Escola Estadual Américo Martins, na região de abrangência do IFNMG/Campus Montes Claros, preparando-os para a participação no processo seletivo para ingresso nos cursos técnicos integrados ao Ensino Médio do IFNMG. A ideia foi colaborar com o desenvolvimento local, especialmente, da região dos bairros do entorno, como o Village do Lago. Dessa forma, a premissa era preparar os alunos para fazer a

prova de seleção do ensino médio do Campus Montes Claros.
Após reunião com diretores das escolas, decidimos que a forma de escolha dos cursistas seria definida pelas escolas, nas quais os alunos interessados eram selecionados (nono ano do Ensino Fundamental).
O interesse era, de fato, estudar no IFNMG, ou seja, o aluno que realmente tivesse interesse se inscreveria para participar.
Antes de iniciar o projeto, foi realizada uma reunião com alunos e pais, explicando o que era o programa e como deveriam se portar na

escola. Logo nos primeiros dias, percebeu-se que um dos empecilhos para o sucesso do projeto seria a má alimentação dos cursistas. Com o intuito de amenizar a situação diagnosticada, foi realizada uma parceria com a Padaria Montes Claros (pães Vinna), que se disponibilizou

fornecer o lanche diário para os alunos. Após resolver esse impasse, os professores criaram seus planos de trabalho e começaram a trabalhar no contraturno (vespertino).

Após um diagnóstico inicial, percebeu-se que os alunos possuíam dificuldades básicas, como ler/interpretar uma questão, o significado de algumas palavras, etc. A professora Luciana dedicou um tempo para esse nivelamento, fornecendo importantes informações sobre a interpretação e análise das questões, antes de iniciar com os conteúdos programados.
Um dos fatores limitantes no projeto foi a falta de internet móvel para os alunos. Muitos deles, em função disso, não realizaram a inscrição, o que, com certeza, será observado no próximo “Pré-Técnico’’.
O programa carece de estudos posteriores para detectar o número de alunos que foram aprovados, ou
Reunião com os pais, evidenciando como seria a aplicação do pré-técnico.
que conseguiram acompanhar os estudos. Seria importante também quantificar e identificar os fatores que levaram alunos a desistirem de continuar os estudos. Sabe-se que alguns tiveram êxito, mas o número certo não está oficializa-
do em pesquisa. Atualmente, sem as provas presenciais, o programa está suspenso e não há professores com interesse em continuar. Esperamos que tenhamos candidatos para manter o curso e que este perdure como política do campus.
Contação - Aprende-se ensinando nos Vales e Gerais

Coordenador: Luiz Carlos Ferreira
Discente bolsista: Juliana Pacheco Magalhães
Discente voluntário: Luana Rodrigues Pimenta Autor do relato de extensão: Luiz Carlos Ferreira
Campus: Januária
Público-alvo: Comerciários e servidores do CDL da cidade de Januária Período: 01/07/2021 a 12/12/2021
Foram feitas análises microbiológicas do ar ambiental em 10 (dez) estabelecimentos comerciais selecionados, em parceria com Câmara de Dirigentes Lojistas (CDL) de Januária-MG. As amostras coletadas para a realização das análises microbiológicas foram acondicionadas em uma caixa isotérmica e transportadas para o laboratório de microbiologia do IFNMG/Campus Januária.

A qualidade do ar das áreas dos
foram encaminhadas ao laboratório de microbiologia do IFNMG/Campus Januária e incubadas a 35ºC, de 24 a 48 horas, para a contagem de aeróbios mesofílicos, 25ºC, de 3 a 5 dias para bolores e leveduras e 37ºC, de 24 a 48 horas para enterobactérias. Os resultados foram expressos em UFC/ cm²/semana.
Após a realização das análises da avaliação microbiológica do ar do ambiente dos comércios selecionados, os resultados foram apresenta-
O comércio da cidade de Januária-MG tem se caracterizado pela alta rotatividade de clientes e, consequentemente, pela multiplicidade de veículos transmissores de doenças. Assim, a avaliação da contaminação microbiológica nesses comércios foi de fundamental importância para garantia de segurança dos serviços prestados e manutenção da saúde dos consumidores. comércios estudados foi avaliada, utilizando a técnica de sedimentação simples em placa de Petri, descrita no Compendium of Methods for the Microbiological Examination of Food (APHA, 2001). Foram utilizadas placas com ágar BDA, ágar PCA e ágar MacConkey, para a contagem de bolores e leveduras, aeróbios mesofílicos e enterobactérias, respectivamente. As placas foram distribuídas pelas áreas dos comércios e expostas por 15 minutos. Depois de fechadas, as placas
dos aos comerciários, por meio de relatório, demonstrando a relação da contaminação do ar e o risco de transmissão de infecções transmitidas por via aérea, como a Covid-19.
Por fim, todos os comerciários envolvidos no projeto foram convidados para uma palestra sobre trans-

missão de infecções por via aérea e Covid-19.

Os resultados serão constantemente compartilhados com os comerciários, para que estes possam se conscientizar da importância da qualidade do ar na transmissão de infecções por via aérea.
Contagem de mesófilos aeróbios, enterobactérias e bolores e leveduras em amostras coletadas do ar de comércios da cidade de Januária-MG



ar.
Espera-se, com este trabalho, demonstrar, para os comerciários dos estabelecimentos envolvidos no projeto em Januária-MG, a importância dos cuidados com do -
enças de transmissão aérea como gripes, resfriados e a Covid-19, conscientizando a população de modo geral sobre os riscos de tais infecções.
Contação - Aprende-se ensinando nos
Coordenador: Luiz Carlos Ferreira
Discente bolsista: Luana Rodrigues Pimenta
Discente voluntária: Brenda Santos Farias
Autor do relato de extensão: Luiz Carlos Ferreira
Campus: Januária
Público-alvo: Servidores de uma escola pública estadual, no município de Januária-MG Período: 01/11/2021 à 01/12/2021
Tratou-se de uma proposta de projeto de extensão voltado para a conscientização de servidores de uma instituição pública de ensino do município de Januária-MG no que se refere à prevenção de infecções como a COVID-19. Foram realizadas demonstrações práticas da eficiências da higienização das mãos no controle de infecções, além de palestra sobre prevenção de doenças infecciosas com ênfase na COVID-19.
 Luana Rodrigues Pimenta
Luana Rodrigues Pimenta
Oprojeto objetivou realizar palestra e demonstrar, de forma prática, o quanto a higienização das mãos é eficiente no controle de infecções. Esperou-se conscientizar servidores de uma escola pública sobre como a higienização das mãos reduz a carga microbiana na pele e tem impacto significativo na manutenção de hábitos de higiene simples, mas eficientes, no controle de infecções.


Foi selecionada uma instituição de ensino da rede estadual, no município de Januária-MG, para participar deste estudo. Da instituição selecionada do projeto, dez servidores participaram do estudo.
Em dias predeterminados, a instituição de ensino recebeu a visita da equipe do projeto, quando foi ministrada uma palestra sobre a
importância da higienização das mãos no controle de infecções, sendo, em seguida, realizada uma demonstração prática da eficiência da higienização das mãos no controle de infecções. Ao final, foi agendado outro dia para que a equipe do projeto retornasse à instituição e apresentasse os resultados da demonstração prática.
A demonstração prática consistiu na escolha de dez servidores voluntários, dos quais foram coletadas amostras das mãos, antes e depois da higienização. Tanto antes quanto depois da higienização das mãos, swabs estéreis foram utilizados para coletar amostras nas mãos dos voluntários. Em seguida, estes swabs foram esfregados em placas de Petri, contendo meio ágar nutriente esterilizado previamente, sendo finalmente as placas transportadas em caixas isotérmicas

para o Laboratório de Microbiologia do IFNMG/Campus Januária-MG, onde foram incubadas em estufa a 35°C, por 24/48 horas. Após o período de incubação, as placas foram mantidas em refrigerador a uma temperatura de 4°C.
Durante a demonstração dos resultados na instituição de ensino, foi possível comprovar para os servidores o quanto é eficiente a higienização das mãos no controle de microrganismos, uma vez que estes puderam visualizar a contaminação das mãos, antes e depois da higienização.
A realização de palestra e demonstração prática da eficiência da higienização das mãos no controle de infecções permitiu aos servidores da instituição participante do estudo se conscientizarem quanto à importância dos cuidados de higiene pessoal no controle de infec-
ções, como a Covid-19.
A colaboração da direção da instituição participante do estudo foi de fundamental importância para realização deste projeto. Este projeto foi, inicialmente, planejado para ser executado também com alunos de escolas públicas e particulares; porém, devido à suspensão das atividades presenciais nas escolas, não foi possível atingir esse público.
Apesar das dificuldades impostas pela pandemia de Covid-19, foi possível executar o projeto para um público de servidores de uma instituição de ensino pública, possibilitando que eles se conscientizassem acerca da importância da higienização das mãos no controle de infecções, além de torná-los multiplicadores dos conhecimentos adquiridos.


Coordenador: Edimilson Alves Barbosa
Discentes bolsistas: Bernardo Almeida Rocha, Tales Cunha da Rocha, Stefany Ferreira Dias Santana, Breno Silva e Castro Moraes, Ernane Júnior Barreto Botelho e Lilian Alves Salomão
Autores do relato de extensão: Bernardo Almeida Rocha, Stefany Ferreira Dias Santana e Edimilson Alves Barbosa Campus: Almenara Público-alvo: Empreendedores da região do Vale do Jequitinhonha afetados pela pandemia
Período: 01/07/2021 a 12/12/2021

Inúmeros empreendimentos foram afetados negativamente pela Pandemia da COVID- 1. Este projeto apresentou ferramentas a recuperação dos mesmos, a partir de um Plano de Ação. A intervenção nas contribuiu para o aumento das receitas e das atividades.
Em 11 de março de 2020, a Organização Mundial de Saúde (OMS) decretou a pandemia do novo coronavírus (SARS-CoV-2), responsável pela pandemia de COVID-19. A partir daquele momento, muitos países implementaram uma série de intervenções para reduzir a transmissão do vírus e frear rapidamente a evolução da pandemia, entre eles, o Brasil. Os lockdown fizeram com que as empresas consideradas “não essenciais” ficassem fechadas por períodos de até 15 dias, repetidas vezes, dificultando a manutenção do pequeno negócio, principalmente aqueles que não tinham nenhum planejamento para crises.
Pensando em contornar essa cri-
se econômica, surgiu o programa IF Mais Empreendedor, que visou, no ano de 2021, atender e apoiar empreendedores, por meio de projetos de extensão. Foi um programa de abrangência nacional, que teve coordenação geral do IFSuldeMinas e adesão de instituições da Rede Federal de Educação Profissional, Científica e Tecnológica de todas as regiões do Brasil.
Dentre essas instituições participantes do programa, o IFNMG/ Campus Almenara atendeu 5 empresas localizadas na sua região de abrangência, pelo período de 6 meses, compreendido entre junho e novembro de 2021. Em razão das orientações para o distanciamento social, as atividades que demanda-
vam reuniões, conversas e/ou apresentação de materiais/informações foram todas realizadas de forma remota, via conversas por WhatsApp e chamadas de vídeo pela plataforma Google Meet.
O projeto “Recuperação do Impacto da Pandemia de COVID-19” contou com 6 discentes bolsistas, entre eles 2 do Curso Técnico em Administração integrado ao Ensino Médio, 1 do Curso Superior de Análise e Desenvolvimento de Sistemas e 3 do Curso Superior de Engenharia Agronômica. Das empresas selecionadas, foram atendidos empreendimentos dos seguintes setores: loja de acessórios e confecções, desenvolvimento social, agropecuário e ambiental sustentável, fotografia,
Contação - Aprende-se ensinando nos Vales e Gerais
confeitaria e limpeza e higienização de ar-condicionado. Esses empreendimentos estão localizados nas cidades de Águas Formosas/MG, Rio do Prado/MG, Jequitinhonha/ MG e Almenara/MG.

Durante a realização do projeto, identificou-se, por meio das entrevistas, que as empresas não possuíam um plano de negócios; então foi realizado um diagnóstico organizacional das empresas e elaborado um Plano de Ação, que serviria como guia nas atividades orientadas, durante todo o período do projeto. Esses planos de ação foram elaborados por discentes após análise de cada cenário. Entre as propostas elaboradas para os empreendimentos, destacam-se ações relacionadas ao marketing e à gestão financeira do negócio, buscando o desenvolvimento da criatividade e da inovação dos empreendedores atendidos e a consequente melhoria nos atendimentos e entrega de produtos e serviços.
Como resultados positivos, evidencia-se que, a partir dos atendi-

mentos e consultorias prestadas a esses empreendimentos, os proprietários dos negócios apresentaram uma visão mais ampla da sua empresa (boa estratégia de marketing, constância nas divulgações realizadas nas redes sociais, controle de caixa para prever futuros lançamentos e saídas, entre outros aspectos trabalhados durante o projeto).

Marlene Medina, uma das empreendedoras atendidas, relata que “mesmo cansada, procurava fazer o que eu não queria mais fazer, ‘o marketing’, que já havia um tempo que não postava nas redes sociais da empresa”. Com isso, reforça a importância que o atendimento teve na sua empresa. A esse respeito, Bernardo Rocha, bolsista do projeto e discente do Curso Técnico em Administração, responsável pelo atendimento dessa empresa, relata que a participação no projeto de extensão permitiu “o contato quase que diário com a empresária, na busca de soluções e de inovações para o empreendimento, fez com que tivesse contato um pouco daquilo que venho estudando no curso técnico, colocando-me como um “administrador” e vivenciando as dificuldades que um empresário tem na gestão do seu negócio. Foi uma experiência única!”.

Coordenadoras: Clara Isabele Silva Sucupira, Maria Victória Rodrigues de Oliveira e Myrian Amaral dos Santos
Colaboradores: Whinne Barony Cordeiro Magalhães e Janaína Mendonça Pereira
Autor do relato de extensão: Ivan Carlos Carreiro Almeida
Campus: Teófilo Otoni Público-alvo: Toda a população da microbacia do Córrego Piquiri Período: 17/09/2021 a 17/01/2022
Ação de mobilização social e conscientização sobre a coleta seletiva e cuidado com o meio ambiente no Bairro Turma 38, cortado pelo córrego Piquiri

Oprojeto de Extensão
Rio Vivo foi idealizado para apoiar as ações da Secretaria de Meio Ambiente e Desenvolvimento Sustentável de Teófilo Otoni (SMMADS) e teve, como meta prioritária, a recuperação da microbacia do córrego Piquiri, que passa próximo ao IFNMG/Campus Teófilo Otoni. A coordenadora Janaína Mendonça, secretária de Meio Ambiente e também presidente do Comitê de Bacias Hidrográficas dos Afluentes do Rio Mucuri (CBH -MU1), convocou parceiros para a missão de promover a revitalização das microbacias do Rio Todos os Santo,s por meio de ações de conservação e recuperação dos recursos naturais.
Para essa missão, o IFNMG foi convidado a participar das ações, por intermédio do professor Ivan Almeida, que é vice-presidente do CBH-MU1 e também secretário do Conselho de Meio Ambiente Municipal (CODEMA), junto com outros parceiros, como o SENAR e a UFVJM. O projeto contou com três bolsistas
e assinatura, junto ao córrego Piquiri, do decreto de criação do Parque Municipal, em companhia do prefeito de Teófilo Otoni, Daniel Sucupira, e da secretária de Meio Ambiente, Janaína Mendonça

do Curso Técnico em Agropecuária, Clara Sucupira, Maria Victoria Oliveira e Miryan Amaral, coordenadas pelo professor Ivan e pela engenheira hídrica Whinne Baroni.
O projeto foi iniciado no dia 27 de maio de 2021, no mesmo dia em que foi realizado o primeiro plantio
no Bosque da Memória Dona Dulce Araújo, em homenagem às vítimas da Covid-19, com o plantio de mudas nativas de espécies da Mata Atlântica.

A bolsista Clara relatou a importância do Bosque para a recuperação da APP, mas, principalmente,
Contação - Aprende-se ensinando nos Vales e Gerais



Marcação de curva de nível para a confecção de terraçosIvan Almeida
Ação de mobilização social e conscientização sobre a coleta seletiva e cuidado com o meio ambiente no Bairro Grão Pará, com voluntários do Save the Green e trabalhadores da ASCANOVICarlos Eduardo Apoio ao Projeto Cidadania e Água Limpa, realizado pelo Internato Rural (Associação Educacional Evangélica Luterana) Miryan Amaral
para ser um local de lembranças e alento para as pessoas que perderam seus entes queridos pela pandemia causada pela Covid-19. Também foram efetuadas ações de mobilização social e conscientização sobre a coleta seletiva e o cuidado com o meio ambiente. Foi realizada uma expedição do Rio Vivo no Córrego Piquiri e foi assinado o decreto para criação do Parque Municipal e a implantação das demais áreas de lazer e bem-estar para as comunidades. Foram realizados o plantio de centenas de mudas às margens do Córrego Piquiri, em um grande mutirão com a comunidade local e a marcação de curvas de nível para futura confecção de terraços, como técnica para conservação do solo das áreas ao redor do corpo hídrico. A bolsista Myrian Amaral relata a importância do projeto para enriquecer os conhecimentos aprendidos nas disciplinas, principalmente a de Solos e Manejo de Bacias Hidrográficas.
O Projeto Rio Vivo apoiou, ainda, o Projeto Cidadania e Água Limpa, realizado pelo Internato Rural (Associação Educacional Evangélica Luterana), o qual promoveu ações de educação ambiental, voltadas, principalmente, para a preservação da quantidade e qualidade das águas nas bacias hidrográficas, promovendo exposições na Praça Tiradentes que é a principal praça da cidade e na AGRIVALES (Feira da Agricultura Familiar e Agronegócio dos Vales). Maria Victória adorou a experiência de participar de ações de educação ambiental e de poder trocar conhecimentos com a população. Para a realização das ações, o projeto contou também com a colaboração de diversos voluntários, principalmente da comunidade do Bairro Viriato, voluntários da ONG Save the Green e da equipe técnica da SMMADS, composta por Janaína Mendonça, Joanne Jardim, João Garcia, Whinne Baroni, Uedio Silva e Tamires Torres.

Contação - Aprende-se ensinando nos Vales e Gerais

Coordenador: Ivan Carlos Carreiro Almeida
Discentes voluntários: Ana Júlia Guedes Abrantes, Ana Luísa Ramos Lins, Geovana Ferreira da Silva, Nathaly Silva de Oliveira, Matheus Rodrigues Santana e João Vitor Lemos Ribeiro de Souza
Colaboradores: Jorge Luiz Moreira e Reslande Lopes
Autor do relato de extensão: Ivan Carlos Carreiro Almeida Campus: Teófilo Otoni
Público-alvo: Estudantes dos cursos de ciências agrárias e produtores rurais Período: 01/11/021 à 31/01/2022
O estado de Minas Gerais é considerado um dos principais pólos agropecuários do país. Considerando o papel fundamental das pastagens para esse setor, este projeto objetivou desenvolver um campo didático experimental para o desenvolvimento das principais espécies de gramíneas forrageiras utilizadas na região.

Na região de Teófilo Otoni, a pecuária possui grande importância e influência na geração de renda e trabalho, principalmente na bovinocultura. Porém, grande parte das terras do Vale do Mucuri se encontram em processo de degradação. Analisando essa re -

alidade, nota-se que, muitas vezes, há grandes prejuízos financeiros e ambientais pela escolha incorreta da espécie/cultivar, de acordo com as condições edafoclimáticas e devido ao manejo inadequado das pastagens. Tendo em vista a grande quantidade de materiais forrageiros disponíveis no mercado, objetivou-
se a implantação de um campo agrostológico, com propósito dispor de um “laboratório a céu aberto”, onde os alunos dos cursos de Ciências Agrárias podem ter pleno acesso e vivenciar, na prática, todas as diferenças e processos na produção de diferentes espécies e/ou cultivares de plantas forrageiras, destinadas à alimentação animal.

O campo agrostológico configura um acervo de espécies forrageiras e tem importância didática, uma vez que, no local em que for implantado, poderá servir como ambiente de estudo prático para alunos, técnicos em cursos especializantes e produtores rurais interessados em melhores desempenhos de forrageiras para pastejo em suas propriedades, levando em consideração as características morfológicas e fisiológicas, como: arquitetura de planta, sincronismo de florescimento, empalhamento, decumbência, tolerância a estresses de seca e temperatura, às pragas e eficiência no uso de nutrientes. O campo agrostológico servirá de painel para a capacitação de alunos e, posteriormente, de produtores rurais, de
Contação - Aprende-se ensinando nos Vales e Gerais
modo a integrar o IFNMG, a comunidade acadêmica e os produtores. Inicialmente, foram implantadas 14 espécies de gramíneas, sendo elas as principais forrageiras implantadas no Brasil, como: Cynodon spp (Tifton); Brachiaria Decumbens (Braquiarinha); Brachiaria híbrida (Convert HD364); Brachiaria brizantha (Xaraés, MG5, Marandu) Brachiaria Ruziziensis (Ruziziensis), Brachiaria humidicola (Llanero), Pennisetum purpureum (BRS Capiaçu, BRS Kurumi); e Panicum maximum (Mombaça, Piatã, Tanzânia, Zuri). O preparo da área e a implantação dos canteiros foram realizadas pelos bolsistas do projeto e todas as etapas de correção de solo, plantio, adubação e manejo foram realizadas junto com os alunos da disciplina de Forragicultura. Com o campo agrostológico, foi possível fazer a mesclagem entre aulas práticas e teóricas, havendo
Forrageiras em desenvolvimento com 25 dias após o plantio
um maior interesse dos discentes sobre a forragicultura e todo o conteúdo que a engloba, e também uma melhora significativa no desempenho dos acadêmicos nas disciplinas que envolviam o campo. A estudante Giovana Silva relata que o campo agrostológico a ajudou a compreender e conhecer melhor as espécies forrageiras; a estudante Ana Júlia relata que o aprendi-
zado ficou mais fácil com as aulas práticas no campo agrostológico. O campo agrostológico se encontra disponível para a visitação da comunidade e produtores rurais e, em breve, serão realizados dias de campo. O projeto será continuado e novas espécies e cultivares serão implantadas, além de gramíneas, leguminosas e cactáceas, que irão compor nossa área de estudos.


Coordenador: Ivan Carlos Carreiro
Discentes bolsistas: Almeida, Ana Luísa Ramos Lins, Catarina Matos Ferraz e Cleide Almeida Coelho Fernandes
Discente voluntária: Ana Júlia Guedes Abrantes
Colaboradores: Honório José Siqueira - Padre da Paroquia São Francisco de Assis de Teófilo Otoni e idealizador do Projeto Frutificar e Douglas Hibner – Técnico do Projeto Frutificar
Autor do relato de extensão: Ivan Carlos Carreiro Almeida Campus: Teófilo Otoni
Público-alvo: Produtores rurais, profissionais e estudantes da área agrícola.
Período: 01/04/2021 à 31/01/2022
O projeto Frutificar possui a missão de promover o bem comum da comunidade e assegurar o desenvolvimento das localidades e a garantia da qualidade de vida do agricultor, por meio da realização de atividades produtivas nas propriedades rurais, de forma sustentável e com geração de renda.
 Padre Honório
Lavoura de videiras em produção no município de Teófilo Otoni - MG
Jussara Gomes da Cruz
Padre Honório
Lavoura de videiras em produção no município de Teófilo Otoni - MG
Jussara Gomes da Cruz
Devido a inexistência cultural de produção na área de fruticultura e horticultura e a falta de assistência técnica na região do Vale do Mucuri, poucos são os produtores rurais que possuem sua principal fonte de renda dependente da agricultura na região.

A horticultura e a fruticultura são atividades agrícolas rentáveis e que demandam bastante mão de obra, sendo uma grande oportunidade para alavancar a economia dos municípios, fixando o agricultor no campo, gerando emprego e renda e alavancando, positivamente, toda a economia da região. A agricultura familiar é um segmento fundamental para o abastecimento alimentar e a geração de ocupações, mas tem sido ameaça-

da pela grande emigração de jovens, em decorrência de transformações ocorridas no urbano e no rural.
Com a intenção de reverter este cenário de êxodo rural e transformar o Vale do Mucuri em um polo agrícola, foi idealizado, pelo Padre Honório, da Paróquia São Francisco de Assis de Teófilo Otoni, o Projeto Frutificar, que veio para encorajar, entusiasmar e mostrar que é possível produzir frutas e hortaliças de qualidade na região. Para isso foi criada uma rede de apoiadores: Prefeitura Municipal, Sebrae, Sindcomércio, Internato Rural, Emater, Unipac e o IFNMG, que contribuíram com a contratação de técnicos para a realização de assistência técnica, subsídio de mudas frutíferas e apoio a seminários e dias de campo para a capacitação dos produtores e técnicos do projeto, visando promover a geração de renda e sentimento de pertencimento à população no território, incorporando o poder de governança local.
O IFNMG contribuiu neste projeto, especificamente, com apoio nas capacitações, como em seminários, cursos e dias de campo, além de ali-
mentar o Instagram do projeto, o @ Frutificar_Mucuri, que divulga diariamente as ações dos técnicos de campo, eventos relacionados com a agricultura e oportunidades de fomentos, mostrando que é possível produzir de forma rentável e sustentável. Hoje já são quase 900 pessoas que acompanham as ações do Projeto Frutificar.


Agricultores como o Edmar e o Milton, da Comunidade Brejaúba, são exemplos de que o projeto vem alcançando êxitos. Os dois tinham propriedades, mas ganhavam seu sustento na cidade. Com a chegada do projeto, foram encorajados a serem
agricultores e, por meio das capacitações e assistência técnica, toda a família trabalha na agricultura e vem obtendo boa produtividade com a produção de graviola, goiaba, citros, uva, acerola e, entusiasmados, estão plantando café conilon e arrendando terras para ampliar as lavouras.
O projeto Frutificar veio para mostrar que, quando pessoas e entidades se unem em prol de uma causa, o sonho torna-se realidade. Hoje o projeto Frutificar vem se expandindo e já faz parte de municípios dos Vales do Mucuri, Jequitinhonha e São Mateus. Acompanhe nossas ações por meio do Frutificar_Mucuri no Instagram.
Contação - Aprende-se ensinando nos Vales e Gerais
Coordenadora: Joyce Meire da Silva França
Discentes bolsistas: Danilo Neres de Souza Rodrigues e Ellton Danilo de Souza Reis
Discente voluntário: Renivaldo Rodrigues dos Santos Autor do relato de extensão: Joyce Meire da Silva França Campus: Porteirinha
Público-alvo: Alunos do ensino fundamental (7°, 8° e 9° anos) da Escola Municipal Dona Gercina Vilas, do município de Porteirinha. Período: 01/07/2021 a 12/12/2021
Esse projeto possibilitou o desenvolvido de um jogo educacional digital denominado H1stori4and0. O jogo aborda um personagem historiador viajando pelos estados do Brasil e em cada estado se depara com desafios matemáticos que abordam cultura, história da cidade e personalidades importantes.
Ojogo H1stori4and0 apresenta um personagem historiador viajando pelos estados do Brasil e, em cada estado, depara-se com desafios matemáticos que abordam cultura, história da cidade e personalidades importantes. A proposta do jogo é aplicar conteúdos de Matemática de forma interdisciplinar com os conteúdos de História e Geografia, para os alunos do Ensino Fundamental (6º a 9º ano).
O jogo educacional foi desenvolvido usando a tecnologia Godot e estruturado no formato de quiz, abordando conceitos de Matemática e História. A versão atual do jogo aborda os estados da região sudeste do Brasil: Minas Gerais, São Paulo, Rio de Janeiro e Espírito Santo. Nas


próximas versões do jogo, almeja-se incluir as demais regiões. A versão atual do jogo possui 24 perguntas que foram apresentadas no forma-
to quiz, com 4 alternativas como opções de resposta. O aluno deve realizar os cálculos matemáticos e escolher a alternativa correta. As
perguntas podem envolver os conteúdos da Matemática, como operações básicas (adição, subtração, multiplicação e divisão), sistemas de numeração (números romanos) e sistemas de medidas (cálculos de área e perímetro).
Um exemplo de pergunta contida no jogo: “A cidade de Belo Horizonte, capital de Minas Gerais foi fundada em 12 de dezembro de 1897, cerca de 150 anos após a criação da primeira cidade mineira, Mariana. Qual opção representa o ano de fundação de Belo Horizonte em números romanos?”. A alternativa correta (MDCCCXCVII) é apresenta-

da em uma das quatro opções.
Nas etapas iniciais do desenvolvimento do jogo, a equipe do projeto buscou definir o enredo, os personagens, o roteiro, o público-alvo, o conteúdo, a dinâmica do jogo e as tecnologias utilizadas no desenvolvimento. A tecnologia escolhida pela equipe foi Godot, pois agrega vantagens como a versão para celular e computador, programação colaborativa e versão de jogo off-line.


Durante uma das etapas de desenvolvimento do jogo, foi realizada uma pesquisa de campo para discutir, com os professores de Matemática, as funcionalidades do jogo. A
professora de Matemática relatou a importância do jogo no processo de ensino da disciplina e manifestou interesse em utilizá-lo em suas aulas, pois percebe que existe dificuldade em despertar o interesse dos alunos, mas existe uma facilidade quando a temática envolve um jogo. Além disso, a professora destaca que seria interessante uma versão que fosse possível jogar utilizando-se o computador, visto que algumas escolas são equipadas com laboratórios de informática para as aulas.
Segundo a coordenadora do projeto, a situação de pandemia dificultou o andamento do projeto, devido ao distanciamento da equipe, atrapalhando a comunicação e atrasando algumas etapas, como a programação do aplicativo, que exige um trabalho colaborativo. Portanto, a versão final do jogo ficou mais simples do que havia sido planejado inicialmente. Os trabalhos futuros incluem inserir um sistema de recompensas, organizar as perguntas num sistema progressivo de dificuldade e inserir todos os estados do Brasil no quiz.
Contação - Aprende-se ensinando nos Vales e Gerais
Coordenadora: Patrícia Conceição Medeiros
Discentes bolsistas: César Augusto Silva Santos e Maylda Gonçalves Barbosa
Discentes voluntários: Bruno Mendes Ferreira, Diana da Mota Guedes e Larissa Alves Pereira
Colaborador: Antonio Fabio Silva Santos Autora do relato de extensão: Patrícia Conceição Medeiros Campus: Januária
Público-alvo: Público interno do IFNMG e comunidade externa Período: 14/06/2022 à 14/12/2022

Asustentabilidade ambiental perpassa por pressupostos sociais, econômicos e ecológicos. A preocupação com o meio ambiente e, mais especificamente, com os resíduos sólidos, vem ganhando notoriedade crescente no âmbito acadêmico, em congressos técnicos, em ambientes parlamentares e junto à comunidade, devido à necessidade da humanidade de fazer algo que minimize os impactos adversos causados pelos resíduos. Neste contexto, o presente projeto vem sendo desenvolvido desde o ano de 2018 e objetiva ampliar as ações que promovam práticas de sustentabilidade

ambiental no âmbito de atuação do IFNMG/Campus Januária, visando a melhorias sanitárias e ambientais voltadas para a temática dos resíduos sólidos.

Esta etapa do projeto foi executada de junho a dezembro de 2021 e todas as atividades previstas foram atendidas, atingindo um público-alvo de 900 pessoas, com ações de conscientização/sensibilização, presenciais e por meio das mídias sociais. Entre os resultados alcançados, podem ser citados: contribuiu com a educação e sensibilização ambiental da comunidade ao entorno do IFNMG/Campus Januária; integrou o ensino, pesquisa e extensão; promoveu iniciativas que expressam o compromisso social das instituições de ensino superior com a educação, meio ambiente, produção e construção de conhecimentos voltados para o desenvolvimento sustentável.
O projeto foi disseminado em mídias sociais, <https:/www.instagram.com/if_sustentavel09>, canais do Youtube e páginas oficiais do IFNMG, além da divulgação dos dados do trabalho em eventos técnicos e científicos, sendo: trabalho premiado por ter sido classificado em primeiro lugar na área de Engenharias no Seminário de Iniciação
Contação - Aprende-se ensinando nos Vales e Gerais

Trabalho premiado por ter sido classificado em primeiro lugar na categoria Ensino/Extensão no Simpósio de Ciências Agrária, setembro de 2021

Científica (SIC 2021) do IFNMG; apresentação do trabalho no Congresso de Gestão Ambiental em Salvador (Congea 2021); apresentação do trabalho no Simpósio de Ciências Agrárias (Sciagro 2021); trabalho premiado por ter sido classificado em primeiro lugar na categoria Ensino/Extensão do Simpósio de Ciências Agrárias.
As oficinas desenvolvidas no projeto de sustentabilidade foram todas incluídas no projeto “Tecnologia e Biodiversidade: Sustentabilidade e Inclusão Digital nos Gerais”, que foi submetido pelo IFNMG na Operação Rondon das Gerais. O projeto ficou em primeiro lugar no Conjunto B “Comunicação, Tecnologia e Produção, Ambiente e Trabalho. O Projeto Rondon é uma ação interministerial do Governo Federal, coordenada pelo Ministério da Defesa, realizada em parceria com as Instituições de Ensino Superior,
Apresentação de trabalho no Congresso de Gestão Ambiental (Congea 2021), em Salvador/BA

e tem, como objetivo, somar esforços com as lideranças comunitárias e com a população, a fim de contri-
buir com o desenvolvimento local sustentável e na promoção da cidadania.
Na avaliação do acadêmico do Curso de Bacharelado em Engenharia Agrícola e Ambiental e bolsista do projeto, César Augusto Silva Santos, algumas características facilitadoras para a execução do projeto foram: o conhecimento teórico adquirido ao longo da graduação; experiência prática para executar o projeto; conhecimento em ferramentas para criação de conteúdos de mídias sociais; bolsistas, voluntários e orientadora empenhados em prol do desenvolvimento do projeto; e reuniões semanais de alinhamento de execução do projeto. A limitação de atividades de forma presencial devido a pandemia foi uma das dificuldades encontradas. Mesmo assim, os objetivos propostos pelo projeto foram alcançados com sucesso e as atividades foram executadas, com êxito, por parte dos integrantes, apesar da dificuldade de ter sido de forma remota, devido à pandemia, obtendo um bom retorno por meio de interação
com os conteúdos digitais disponibilizados.
Para a acadêmica do Curso de Bacharelado em Engenharia Agrícola e Ambiental e bolsista do projeto, Maylda Gonçalves Barbosa, o projeto em ação possibilitou, mesmo que remotamente, o envolvimento com os demais públicos na busca de soluções para os problemas de resíduos. Por meio das mídias sociais, foi possível difundir conteúdos digitais, promover interação e trocar informações sobre conscientização/ sensibilização ambiental. A situação de pandemia e restrição sanitária foram alguns dos obstáculos e barreiras encontrados pela equipe e limitaram a busca de parcerias para ampliar as ações para um público ainda maior. A oportunidade de participar de um projeto de extensão desenvolveu habilidades como: autonomia, pensamento crítico para a solução de problemas, amadurecimento e responsabilidade. A troca de conhecimento e experi-
ência contribuíram para despertar, ainda mais, o interesse pela área da sustentabilidade e resíduos sólidos.
Para a acadêmica do Curso de Bacharelado em Engenharia Agrícola e Ambiental e voluntária do projeto, Diana da Mota Guedes, que apresentou o trabalho “Ações de sustentabilidade ambiental com ênfase nos resíduos sólidos no âmbito de atuação de um campus da rede federal de ensino”, de forma presencial, no Congresso Brasileiro de Gestão Ambiental, na cidade de Salvador/BA, a apresentação buscou divulgar ações desenvolvidas pela equipe, chegando à conclusão de que a Educação Ambiental é um relevante instrumento para que as Instituições de Ensino proporcionem reflexões, sensibilizando e conscientizando acerca da sustentabilidade. Outra experiência de grande importância para a sua formação acadêmica e para a geração de multiplicadores e conscientização das comunidades acerca
Contação - Aprende-se ensinando nos Vales e Gerais

das questões ambientais foi a sua seleção para participar do Projeto Rondon, representando o IFNMG. Assim, serão apresentadas, à comunidade, algumas oficinas que foram desenvolvidas pela equipe do Projeto de Sustentabilidade Ambiental.


Ao oferecer as oficinas e palestras do projeto em eventos, foi necessário fazer uma adaptação em seu formato, deixando-as mais compactas e com menor tempo de duração para adaptá-las ao formato online.
As ações do projeto continuam em andamento e, após o projeto ser trabalhado dentro da instituição e formar multiplicadores, percebeu-se a necessidade de extrapolar os muros da escola e difundir as práticas de sustentabilidade para a comunidade de um modo geral. Dessa forma, destaca-se a importância do desenvolvimento de projetos de sustentabilidade e educação ambiental no âmbito de atuação das instituições de ensino e no seu entorno, para um maior alcance de pessoas e para dar visibilidade às questões ambientais.
Como envolve questões culturais e mudanças de paradigmas e rupturas com velhos hábitos e costumes, as ações do projeto precisam ser constantes.

Área de disposição final dos resíduos sólidos urbanos gerados no município de Itacarambi - MG (lixão a céu aberto), julho de 2021

Coordenadora: Patrícia Conceição Medeiros
Discentes bolsistas: Dianielle Caroline Antunes dos Anjos e Tamires Santos Andrade
Discentes voluntárias: Samara Bizerra de Oliveira e Maylda Gonçalves Barbosa
Colaborador: Antonio Fabio Silva Santos
Autora do relato de extensão: Patrícia Conceição Medeiros Campus: Januária
Público-alvo: Comunidade em geral do Município de Itacarambi-MG
Período: 14/06/2022 à 14/12/2022
no município de Itacarambi-MG com ênfase nos resíduos sólidos
Este trabalho promoveu práticas de sustentabilidade ambiental no município de Itacarabi/ MG, visando melhorias sanitárias e ambientais locais.
Tamires Santos AndradeApreocupação com o meio ambiente não é recente, mas foi nos últimos anos que essa temática ganhou notoriedade e ubiquidade, envolvendo tudo e todos, o que tornou imperativo difundir ações de sensibilização ambiental dentro e fora dos espaços escolares. Assim, este trabalho apresenta ações do Projeto de Sustentabilidade Ambiental, que objetivaram ampliar e promover práticas de conscientização/sensibilização, com ênfase nos resíduos sólidos, no âmbito de atuação do Instituto Federal do Norte de Minas Gerais.
Dados de pesquisa do projeto levantados no ano de 2020 evidenciaram que as ações do projeto precisam ser ampliadas, e que um projeto desta natureza contribui para melhorar a qualidade de vida da população, preservar o meio ambiente, além de diminuir o volume e os impactos negativos causados pe -


los resíduos sólidos. Assim, as ações deste projeto foram direcionadas para o município de ItacarambiMG, que está inserido na área de abrangência do IFNMG/Campus Januária, no grupo de municípios do Consórcio de Desenvolvimento Ambiental do Norte de Minas Gerais (CODANORTE) e nos domínios da bacia hidrográfica do Rio São Francisco.
A metodologia de execução do projeto foi desenvolvida com base na indissociabilidade do ensino, pesquisa e extensão. Os dados levantados neste trabalho subsidiarão um Trabalho de Conclusão de Curso (TCC) do Bacharelado em Engenharia Agrícola e Ambiental. As atividades foram planejadas com o intuito de: 1) integrar o ensino, pesquisa e extensão; 2) fortalecer o campo da extensão e formar multiplicadores na temática ambiental; 3) despertar o interesse da população

Contação - Aprende-se ensinando nos Vales e Gerais

para a problemática da geração e disposição final de resíduos sólidos; 4) identificar os grupos de atores sociais relacionados ao lixão municipal de Itacarambi- MG, considerando o perfil socioeconômico; 5) levantar os tipos de impactos ambientais e sociais decorrentes da disposição dos resíduos sólidos urbanos no lixão.
Devido ao contexto de pandemia desencadeada pela COVID-19, entre as lições aprendidas, pode ser destacado o gerenciamento do escopo do projeto, incluindo as ações necessárias e possíveis de serem desenvolvidas, com toda segurança sanitária, observando os protocolos vigentes na execução das ações. O gerenciamento de novas formas de comunicação com a comunidade foi um desafio e envolveu estudos e capacitação da equipe, para estabelecer um elo entre as pessoas, as ideias e as informações. Dessa forma, ao desenvolver este projeto, foi necessário aprender novas ferramentas de comunicação digital para reuniões e aplicar ferramentas de comunicação e informação, para desenvolver conteúdos digitais que pudessem ser difundidos em mídias sociais e chegar até as pessoas. Em outros momentos, as atividades de conscientização e sensibilização ocorreram de forma presencial, seguindo os protocolos de segurança sanitária estabelecidos.
Na avaliação da acadêmica do Curso de Bacharelado em Engenharia Agrícola e Ambiental e bolsista do projeto, Tamires Santos Andrade, o projeto desenvolveu muito o seu conhecimento na área de resíduos sólidos. A participação em alguns eventos aumentou o contato com profissionais técnicos da área. O apoio da Prefeitura de Itacarambi agregou, consideravelmente, nas ações do projeto e vivências da forma de trabalho no município com relação a resíduos sólidos e formas de disposição final. As capacitações para elaborar os conteúdos digitais e organização de oficinas aprimora-

ram sua experiência de comunicação, contribuindo, assim, para a sua formação.
Para a acadêmica do Curso de Bacharelado em Engenharia Agrícola e Ambiental e bolsista do projeto, Dianielle Caroline Antunes dos Anjos, a parceria com a Secretaria de Agricultura e Meio Ambiente da Prefeitura de Itacarambi e contato com o Consórcio de Desenvolvimento Ambiental do Norte de Minas (CODANORTE), com o grupo de voluntários “Acelera Peruaçu” e as reuniões semanais com a equipe, para planejamento de todas as ati-
vidades que foram executadas, ao longo do projeto, foram algumas das características facilitadoras para o êxito do projeto. Uma das dificuldades encontradas foi o contato com os catadores, pois o município de Itacarambi não tem Associação dos Catadores de Materiais Recicláveis.
O projeto foi executado de julho a dezembro de 2021 e todas as atividades previstas foram atendidas, atingindo um público-alvo de 800 pessoas com ações de conscientização/sensibilização, presenciais e por meio das mídias sociais.
Ação de conscientização ambiental, mutirão de limpeza no Cais, município de Itacarambi-MG, com a participação e realização da ONG Acelera Peruaçu e bolsistas do projeto, em outubro de 2021

Ação de conscientização ambiental no município de Itacarambi-MG, dezembro de 2021

Catadoras saindo para coleta de materiais recicláveis na cidade de Salinas-MG

Esse projeto começou com a ideia da criação de um aplicativo de celular que pudesse permitir a conexão dos cidadãos interessados em destinar o material do lixo para a reciclagem com a Associação de Catadores de Material Reciclável de Salinas-MG (ASCASAL). E, além do aplicativo, seria necessária a conscientização da população de Salinas-MG sobre a importância da realização da coleta seletiva e da reciclagem, por meio de um trabalho educativo.

E, aí, fomos nós à frente desse desafio, em período de pandemia, em julho de 2021! O professor doutor Leonardo Humberto Guimarães Silva selecionou os discentes para trabalharem com o desenvolvimento do software: Nífane Borges Guimarães (Curso Técnico Integrado em Informática), Antônio Carlos Ramos Filho e Guilherme Santos Gomes (Curso Superior de Bacharelado em Sistemas de Informação). Já a obtenção de informações sobre o funcionamento da ASCASAL e a divulgação de informações para a população ficou sob a responsabilidade da professora mestra Cristiane da Silva Melo e do discente Gustavo Souza Dias (Curso Técnico Integrado em Agroindústria). Todo o trabalho
ocorreu em equipe e de forma colaborativa.
Conscientes de que na natureza nada se cria, nada se perde e tudo se transforma, mas que existem materiais que demoram MUITO tempo para se transformar, gerando poluição ambiental, o trabalho foi iniciado. O desenvolvimento do projeto foi gerenciado pela metodologia ágil Scrum, com o suporte da ferramenta Jira e as reuniões ocorreram por videochamada pelo Google Meet. Ainda ocorreram encontros presenciais da equipe nas visitas à ASCASAL e reuniões com servidores municipais.
Para divulgar a importância da
coleta seletiva e reciclagem e da ASCASAL, criamos o perfil do Instagram @reciclae.ifnmg. Foram realizadas 16 publicações com informações que foram obtidas durante o projeto. O perfil tem 238 seguidores e as publicações realizadas alcançaram um pouco mais de 800 contas. Alguns seguidores da conta interagiram com o perfil, como a catadora da ASCASAL, Juliana Santos Ribeiro, que comentou: “Tenho orgulho do meu trabalho, é digno e merece ser olhado mais pela sociedade porque é o bem do nosso planeta.” Acredita-se que a divulgação dos conteúdos gerou uma maior conscientização, da população alcançada, sobre
Contação - Aprende-se ensinando nos Vales e Gerais

a importância da coleta seletiva e da reciclagem. O perfil ajudou também a divulgar a ASCASAL e suas ações.

O aplicativo foi desenvolvido durante todo o período de execução do projeto, mas ainda não foi finalizado. Ele recebeu o nome de Reciclaê e uma logomarca. O projeto da interface do aplicativo/website (front-end) foi realizado utilizandose a ferramenta de design Figma (https://www.figma.com/file/IqiUQwC12Lt5pEn7z0qURS/Reciclae?node-id=0%3A1). A implementação do código-fonte foi realizada utilizando o framework React-Native, e o Github (https://github.com/leonardo-silva/reciclae) foi utilizado para a hospedagem e controle de versão.
Todos os discentes integrantes disseram que aprenderam muito com o projeto em vários aspectos. Segundo o estudante Gustavo: “De uma forma geral, o projeto me engrandeceu muito como cidadão. Também reforcei a questão de trabalhar em equipe, pois sem um trabalho conjunto, o projeto não teria saído do papel!”
E você? Já se conscientizou sobre a importância de destinar adequadamente o lixo que produz? Vem com a gente e Reciclaê!



Ano: 2019
Fotografia: IFiltrados – Comitê de Imprensa do IFMundo Campus: Almenara
Descrição: O IFMundo é um modelo de simulação, em menor escala, dos comitês da Organização das Nações Unidas (ONU). Trata-se de um projeto de ensino promovido pelo Instituto Federal do Norte de Minas Gerais. Em Almenara, a 3ª edição do evento ocorreu nos dias 10, 11 e 12 de junho de 2019. O público alvo do projeto foram os estudantes do Ensino Médio. Comitês e embaixadas são coordenados, organizados e compostos pelos próprios estudantes. Além disso, no IF Mundo Almenara, os alunos da rede estadual de ensino da região se juntaram aos alunos do Campus para os debates, enriquecendo as discussões.

Ano: 2018
Fotografia: Arquivos da instituição
Autores: Felipe Matos Marques e Comunidade Quilombola do Paraguai Campus: Almenara
Descrição: A III Mostra de Dança e a II Mostra de Linguagens do Campus Almenara ocorreu nos dias 19 e 20 de novembro de 2018, com o tema Raízes, abordando as culturas africanas, afro-brasileiras, indígenas e de povos nativos de outros continentes. Este projeto foi a culminância do trabalho Interdisciplinar das disciplinas de Língua Portuguesa, Literatura, Língua Inglesa, Língua Espanhola, Artes, Educação Física e História, envolvendo as turmas dos 1º, 2º e 3º anos dos cursos Técnicos de Nível Médio (Zootecnia, Agropecuária, Informática e Agropecuária em regime de Alternância). Em 2019, ocorreu a III Mostra de Linguagens com a inclusão das disciplinas de Geografia e filosofia, apresentando a temática “O Negro nas Américas ao Longo da História”, além da participação do 1º ano do curso Técnico de Nível Médio de Administração, também presente na IV Mostra de Dança, cujo tema foi “Volta ao Mundo”.

Título: Poema “96%”
Ano: 2019
Autora: Kaylane Pinheiro Estudante egressa do IFNMG - atuante no projeto de extensão “UneVerso” Campus: Almenara
Descrição: No poema “96%”, escrito em 2019, a poeta Kaylane Pinheiro, aluna egressa do IFNMG – Campus Almenara, atuante no projeto de extensão “UneVerso”, apresenta uma inusitada reelaboração do poema do fim do século XIX “O Adormecido do Vale”, do poeta francês Arthur Rimbaud. Em vez de um soldado ensanguentado que contrasta com uma paisagem acolhedora e exuberante, como expressaria o poema francês, a obra de Kaylane opera interessantes confusões do corpo humano com o ambiente natural, com efeito, o corpo dilacerado se sente desconfortável, mas, de modo surpreendente, está acostumado ou acostumando-se às crises de ambiente, o que não elimina a dramaticidade desse encontro corpo-vale: “A pele afogada pelos riachos \ Que saem pelos olhos cansados”, repensando-se, num momento histórico em que o cuidado com a esfera ambiental seja algo urgente e delicado, uma revisão desse conflito fundamental, a guerra fundamental ao que circunda esse soldado, o humano insano, “Que luta vida \ Vida não sente”.
Contação - Aprende-se ensinando nos Vales e Gerais
No campo mental Do verde transparente O cheiro molhado inunda
A pele afogada pelos riachos Que saem dos olhos cansados No leve “laranjar” da manhã Do sol que queima e traz peso Do remédio insônia constante Arde no peito do soldado Que luta vida Vida não sente
As feridas pintadas de vermelho corante No peito da mente, urgem Alagadas de álcool E palavras pluma de ferro Brotam dali flores mortas que choram Regando os sentimentos adormecidos No vale da fome de sanidade.

Ano: 2020
Autor: Professor Ernani Calazans
Campus: Araçuaí
Descrição: Esta imagem faz parte do Projeto de Extensão “Tenho uma foto pra te contar” coordenado pelos professores Ernani Calazans e Lillian G. de Melo do campus de Araçuaí.
Casa de família - Comunidade de Córregos das Velhas Araçuaí - Vale do Jequitinhonha - MG
Contação - Aprende-se ensinando nos Vales e Gerais

Ano: 2020
Autor: Professor Ernani Calazans Campus: Araçuaí
Descrição: Pintura sobre papel. Essa Arte foi produzida pelo Artista Visual Ernani Calazans e ompõe uma das séries de seus cartões postais de Natal. A imagem traz a família composta por José, Maria e a criança nascida. As riquezas das famílias dessa região são ganhos das mãos dos trabalhadores rurais.

AliceAno: 2020
Autor: Professor Ernani Calazans
Campus: Araçuaí
Descrição: Poema que compõe o livro “Da Taia ao filtro” de Ernani Calazans
Contação - Aprende-se ensinando nos Vales e Gerais
Numa poltrona repousava Alice, Num momento de descanso uma leitura fazia, Na poltrona que Alice repousara, Um dia repousou sua tia. Num banco sentava Alice, Num momento de descanso estava ela e João, No banco que Alice sentara, Um dia sentou com seu irmão. Numa cozinha cozinhava, Alice, Num momento de descanso o feijão temperou, Na cozinha que Alice cozinhara, Um dia sua mãe cozinhou. Numa cristaleira guardava Alice
As peças que no casamento ganhou, Na cristaleira que Alice guardara, Macau, sua avó já guardou. Numa bacia lavava, Alice
As roupas que o marido sujou, Na bacia que Alice lavara, Sabão de bola, por muito gastou. Um ferro à brasa, esquentava Alice Num momento de descanso Lençóis ela passou,
O ferro que Alice assoprara Sua mão, por tanto queimou. Uma mala pegava Alice, Num momento de tristeza suas roupas guardou. Na mala que Alice arrumara, As lembranças de casa com ela levou.
Ano: 2022
Autor: José Renato Teixeira Almeida Discente do 3° ano do técnico em informática integrado no IFNMG Campus: Arinos
Contação - Aprende-se ensinando nos Vales e Gerais
Quem saberá isso responder?
Uns dirão ação, outros dirão meus feitos, difícil conclusão... Ser é muito próximo a fazer. Mas tu sabes quem mesmo é você? O que você crê que identifica seu ser? São, estão, vão…
Tudo além do que a sociedade vê. Sociedade será ainda irracional?
Como se a sua e a minha construção estivessem em um espaço amostral. Mas ninguém me explica o que é ser normal? Sem a hipocrisia, sobra algo no final? Mas, da mesma forma que não sei onde ressoou, Sei que sou humano. Sendo humano, sou profano. Sujo, limpo Mundano, marciano Fêmea, macho. Macho fêmea, Fêmea macho. Para que se classificar? Sendo tudo bicho humano, Ainda classificados como racionais. Além disso, sobra-me perguntar: o que sou?
Ano: 2021
Autora: Jacqueline Moura Ferreira Campus: Arinos Colaboração: Antonio Dias e José Idelbrando
Contação - Aprende-se ensinando nos Vales e Gerais
Eh! Sertão Veredas! Cuida bem dos filhos teus Saudade do povo simples E das belezas que Deus deu Vou voltar para minha Arinos Pois a saudade aqui doeu
Amo descer a serra, Entre os vales e as curvas No tacho o Baru torrar É tradição e é Cultura
No Grande Sertão Veredas São Romão e Riachinho
Em SAGARANA festeja E tem a festa do Bonito
No passo da Siriema No canto do sabiá Araras colorem o céu No novo dia ao sol raiar
É linda a barra da Vaca Berçário da minha Arinos Tem Mangues e Sagarana Caiçara e Rancharia
Tem a ColôNia dos Ciganos, Paulo Freire e P.A Roça E a Vila Bom Jesus Quanta gente, quanta história!
As águas do Rio Claro, São Domingos e Piratinga, São as mesmas do Urucuia que refresca minha Arinos
Comi um biscoito doce Lá na Fazenda Menino E pão de queijo quentinho É novo dia em Arinos
Tuiuú, Maracanã, Tanaçu e carcará, Beija flor, Arapacú Canindé e Sabiá
Canário, João de barro O tucano e o Irré Andorinha e a jandaia Soldadinho e irerê
Eloi Ferreira, Lamarca P.A Santa Terezinha, Rio Claro e Boqueirão Banco da Terra e Igrejinha Pesqueiro e São Gonçalo Angical e Tamboril Vereda do Mel e Pedrinhas Nossa cidade mãe: Morrinhos
Com Pandeiro e a Viola A folia e a cavalgada E não falta a onça parda Andando LIVRE PELA MATA
Chico Mendes e Rio Claro, Mimoso e Grande Borá, Para Terra, Carro Quebrado Santo António dos Gerais
Tem quem atravessa a cavalo
O São Miguel e o Extrema Pacari, Ribeirão Marques E o Ribeirão de Areia
E bom ouvir o Sr Zé De chapéu e pé rachado, Porque ele sabe bem mais Que os Doutor lá da cidade
E com palheiro na orelha, Conta com sabedoria, Que é no Sertão Veredas, Que se vê o bom da vida.
Ano: 2022
Autora: Professora Marli Fróes (poema e fotografia) Campus: Diamantina
Descrição: Vista da vila operária, Largo Dom João (Dimantina-MG)
Contação - Aprende-se ensinando nos Vales e Gerais
Casas apinhadas nervosas por espaço algumas descem ladeiras como garotos em carrinhos de rolimã outras, crianças brincantes, esquecidas do tempo algumas, travessas, sobem o morro tentam tocar o Itambé e suas nebulosas o sol ourifica as serras de Minas tons lilases, azuis, rosáceos e o laranja enlouquecido de Van Gogh preanuncia a noite estrelada

Homens e mulheres descansarão resolutos da vida ou com infindáveis dúvidas amores prometidos, amores rompidos, segredos, revelações...
A vida pulsa para além das janelas E o pulso compassado me revela a tela e as mãos ágeis... pincéis, tinta, aquarela viva da vila
Ano: 2022
Autores: Ellen Cristina, José Renato, Maxwel Moura Discentes dos cursos técnicos integrado ao ensino médio em agropecuária e informática, do campus Arinos Campus: Diamantina
Descrição: Nossa obra retrata a relação de solo e pele, retratando a forma que nós relacionamos e nos reconstruímos. Sendo assim “Tato” se torna sigla para: Transformando o amor Transmutando opiniões
Contação - Aprende-se ensinando nos Vales e Gerais

Ano: 2022
Autora: Ana Lívia Marcelly Pereira Aluna do do 3º ano do Curso técnico de Teatro Campus: Diamantina
Descrição: Tinta acrílica sobre tela, pintura digital. Tela 40x30. O tema da pintura é a rua Campos Carvalho., que é constantemente decorada de diferentes modos, entre eles com guarda chuvas.


Ano: 2018
Autora: Professora Hellen Vivian Moreira dos Anjos, professora EBTT

Campus: Janaúba
Fotografias: Departamento de Comunicação do IFNMG Descrição: Apresentação do grupo músico-teatral, culminância do projeto de extensão “Cantando o Gorutuba” que buscou conhecer a cultura gurutubana e resgatar as canções que fazem parte do cotidiano dessa comunidade. Os gurutubanos, segundo relato oral, originaram-se de índios Tapuias, mescla de um povo cafuso ou caburé, e quilombolas negros que habitam o vale do rio Gorutuba desde o século XVIII. As canções fazem parte da trajetória gurutubana estando ligadas ao universo das lavadeiras do rio Gorutuba e as manifestações culturais religiosas como Dança do Pote, Batuque e danças de chamamento à chuva. A formação do grupo músico-teatral levou aos eventos municipais, regionais e para comunidade do IFNMG as canções que fazem parte da história e identidade dos gurutubanos.
Contação - Aprende-se ensinando nos Vales e Gerais

Contação - Aprende-se ensinando nos Vales e Gerais


Compreendemos que a cultura produz de forma eficaz a formação dos pilares fundamentais da sociedade, já que atua como ferramenta de fortalecimento das identidades coletivas, gera o sentimento de pertencimento social, e age como um poderoso instrumento de inclusão social.
Assim, com o objetivo de desenvolver momentos de expressão cultural, o campus Januária, ao longo dos anos, tem investido em diversos momentos que possibilitam a interação entre a comunidade estudantil e local contribuindo para promover o respeito à diversidade cultural e à criatividade humana, além do mais proporciona aos nossos discentes, desenvolver aptidões para a vida e para a construção de novas realidades. Os produtos gerados por esses momentos, tem possibilitado conhecer nossa cultura local, seus aspectos mais marcantes, e ainda, transformar ideias, conceitos e interesses em ações concretas e duradouras.
Em colaboração com diversos núcleos que compõe da nossa Instituição, temos uma trajetória de incentivo à cultura, principalmente a partir de 2015, quando foi constituído o NEABI - Núcleo de Estudos Afro-Brasileiros e Indígenas, que tem como função de auxiliar no direcionamento de estudos, pesquisas e ações de extensão que promovam a reflexão sobre as questões étnicoraciais, diversos projetos de ensino e extensão foram desenvolvidos. Alguns desses, disponíveis no site da Instituição apresentam diferenciadas formas de apresentações artísticas, proporcionando espaço para o protagonismo criativo dos estudantes.
Tais projetos têm promovido o intercâmbio entre os grupos artísticos tradicionais locais e regionais, despertado talentos, incentivado novos públicos, permitindo a reflexão crítica sobre diversas temáticas e incrementado o nível cultural da nossa instituição.
Campus: JanuáriaContação - Aprende-se ensinando nos Vales e Gerais







Ano: 2018
Autor: Alysson Aziel Silva Lopes Campus: Januária
Saudade que dói, Que bate, Que destrói. Destrói o bem estar, Parece que vai ficar, Que não vai passar, E vai se hospedar. Saudade que aflige, Lembranças que infligem, Infligem a tristeza constante De lembrar daqueles instantes, De um dia normal de estudante. Não se preocupem Isso vai passar, Essa saudade iremos matar, E aquela normalidade que já vivemos, Certamente iremos retornar.

Ano: 2020
Autora: Nathalia Ursine Campus: Janaúba
Descrição: Esse foi o trabalho vencedor na categoria Artes Visuais de autoria da discente Nathalia Ursine, durante o I Show de Talentos do IFNMG - Campus Montes Claros, realizado durante a pandemia de forma virtual em 2020. Evento sob coordenação do Prof. Pedro Henrique de Oliveira Gomes, contou com trabalhos nas categorias “Artes Visuais”, “Música”, “Poesias”, “Esportes” e “Tutoriais”, contando com a comunidade de bancas específicas para seleção dos melhores trabalhos

Contação - Aprende-se ensinando nos Vales e Gerais


Contação - Aprende-se ensinando nos Vales e Gerais



Ano: 2018
Autora: Professora Valesca Rodrigues de Souza Campus: Montes Claros Organizadores: NEABI (Núcleo de Estudos Brasileiros e Indígenas)

Ano: 2011
Autor: Wellington Ricardo Santos Rodrigues Campus: Montes Claros Organizadores: NEABI (Núcleo de Estudos Brasileiros e Indígenas)
Descrição: Wellington Ricardo Santos Rodrigues é servidor do IFNMG- Campus Montes desde 2010. O presente poema consta do livro Antologia do Psiupoético 25: 01 Quarto de Século do Salão Nacional de Poesia Psiu Poético... São Paulo-SP.: Editora Catrumano., 2011 (Poemas). Participou ainda das Antologias dos anos 2000, 2001, 2007 e 2011
O Senador da República só deu um telefonema pro compadre seu que faria a seleção de candidatos ao cargo de despachante do setor público.
Não deu outra. Seu afilhado nem chegou na sala para entrevista e foi direto assinar as papeladas de seu novo emprego com uma secretária gostosíssima à sua disposição, sala própria com ar condicionado, cafezinho, jornais, plano de saúde, plano de previdência social, carro com motorista e horário de “trabalho” à escolha, talvez nem precisasse, bastasse somente ir buscar seu pagamento no dia do recebimento.

Ano: 2022
Autor: Jonathan Rodrigues Azevedo Professor do EBTT Campus: Pirapora



Ano: 2022
Autor: Key (Keyte Macedo)
Aluna do integrado - Vendas - 1º ano Campus: Pirapora
Contação - Aprende-se ensinando nos Vales e Gerais
O vento faz carinho em meu rosto o sonho me leva distante minha alma passeia nos montes meu corpo anseia de monte
a natureza me chama e grita às vezes não ouço, meu coração grita e o ecô ninguém ouve distante e silenciada perdida nos montes pedindo socorro e cansada pois o ecô ninguém ouve
rabiscando à procura de paz o ar faltando e me encontrando o mar me chamando e gritando agora ouço, mas não corro
fechei os olhos e o futuro me esqueceu procurando sentido perdi o rumo de tudo o tudo não me é nada automaticamente não me coube em minha própria vida não me há espaço.
Ano: 2018
Autor: Rony Enderson de Oliveira Pró-reitor de Extensão e Cultura do IFNMG Reitoria
Descrição: Moradora da fazenda São João, Montes Claros - MG. Fotos tiradas durante o trabalho de campo da pesquisa de mestrado: PROGRAMA DE AQUISIÇÃO DE ALIMENTOS E SEGURANÇA ALIMENTAR E NUTRICIONAL: o caso de Planalto Rural no Norte de Minas Gerais.
Contação - Aprende-se ensinando nos Vales e Gerais

Contação - Aprende-se ensinando nos Vales e Gerais

Ano: 2009
Autor: Warley Souza Dias Coordenador da Coordenação de Cultura, Artes, Desporto e Memória do IFNMG Reitoria
Descrição: Desenho em nanquim. Obra de caráter alegórico inspirada no mito de Zeus e Antíope. A imagem tem como cenário a Igreja Bom Jesus de Matozinhos, localizada na Barra do Guaicuí (distrito de Várzea da Palma). No primeiro plano, uma criatura mítica, cujo aspecto lembra um louva-deus, espreita uma negra prostrada sobre um antigo sofá
Contação - Aprende-se ensinando nos Vales e Gerais

Volta e meia minha filha de dois anos reivindica ir comigo ou com a mãe “trabalhar”, afinal na cabeça dela toda saída de casa, com exceção dos exames médicos, é, naturalmente, para algo mais divertido do que a casa, sob pena de não fazer sentido sair do conforto do lar. Mas, tudo bem, a criança não tem projeção de longo prazo. A relação de causa e efeito entre o trabalho e o financiamento do pula-pula ainda não lhe faz sentido. “Se todos os dias papai e mamãe saem de casa e ficam horas e horas ‘trabalhando’, coisa ruim num deve ser, porque se fosse, qual seria a utilidade?”, pensa ela.
Para piorar, algumas vezes já a levamos para visitas aos nossos locais de labuta. Gente do nosso tamanho sorrindo, computador pra todo lado, ofertas de coisas para brincar, telefone fixo, calculadora, espaço de sobra, salas de aula, papéis e canetas dando sopa. “Assim eu quero trabalhar também!”, deve pensar. É tanto que de vez em quando, ao ir para a escolinha, solta que “está indo trabalhar”, afinal, lá ela também segue regras, faz tarefas, escreve em papéis, vê gente do tamanho dela sorrindo.
Mas nada é tão simples que não possa se complexificar. De vez em quando, ao chegar em casa e liberar a babá, minha filha pergunta a ela: “Está indo trabalhar?”. Tentamos explicar, provavelmente sem sucesso, que o trabalho dela é ficar na nossa casa, no lugar que deixamos quando precisamos ir trabalhar e de onde depois ela vai embora cuidar da filha dela, que é cuidada pelo trabalho de uma outra pessoa. “Ahn?”.
Essa confusão me fez refletir: Qual sentido tem no meu trabalho? Será que eu me divirto? Valorizo o sorriso das pessoas? Que espaço estou ajudando a construir? Escuto as histórias e demandas dos colegas com paciência, como se criança fossem? Enfim, o trabalho é só uma ferramenta para obter algo, para dar algum resultado objetivo, ou também pode ser um espaço de fruição, de troca, de prazer e de amor?
Rubem Alves, em “A educação dos sentidos”, diz que carregamos duas caixas: uma de ferramentas, de coisas “úteis” e outra de brinquedos, de coisas para fruir, desfrutar, amar por elas mesmas; e que temos uma sólida concepção de que não faz sentido gastar tempo com essas “inutilidades” da segunda caixa. De fato, não há o que fazer com uma música de Tom Jobim, um poema de Cecília Meireles, um quebra-cabeças. Mas, completa Rubem, “a vida não se justifica pela utilidade, mas pelo prazer e pela alegria”. Que nós possamos conseguir, como quer ele e minha filha, ter “inutilidades” nas nossas “utilidades”.
Ano: 2021
Autor: Álef Vinícius Rodrigues de Freitas Discente do 3º Ano do Curso Técnico em Agropecuária Campus: Salinas
Descrição: Fotografia digital. Projeto realizado para ressaltar a Beleza Negra em seus diferentes traços e estilos. O dia 20 de novembro é uma data para reconhecer a nossa luta diária contra o desprezível e nojento racismo, que ainda infecta todas as áreas da sociedade. Todas! Esta é uma das fotos do projeto em que eu junto com minhas modelos posamos seminus de forma artística, mostrando todo nosso empoderamento e beleza
Contação - Aprende-se ensinando nos Vales e Gerais

Ano: 2021
Autor: Samuel Costa Barbosa Discente de Licenciatura em Ciências Biológicas Campus: Salinas
Descrição: Técnica de aquarela botânica
Contação - Aprende-se ensinando nos Vales e Gerais


Ano: 2021
Autora: Samira Ribeiro Dias Discente do 3º Ano do Curso Técnico em Agroindústria Campus: Salinas
Aperriada
Totalmente esgotada Vivendo sem graça sem nada Tentando guardar o resto de esperança que se esgota a cada segundo Acabada
simplesmente agoniada Vivendo normalmente esperando o amanhã que chega igual o ontem Totalmente sem graça sem nada Chateada Meramente cansada Nunca existiu graça e nem nada E a esperança coitada se esgota a cada segundo
Por minha sorte lá no fundo sempre tem um restinho de esperança guardada.

Ano: 2019
Autores/Organizadores: Alunos do 2º e 3º anos dos cursos técnicos Campus: Teófilo Otoni
Descrição: Apresentação de Trabalho da Disciplina de Português da Prof. Virginia de Souza Avila Oliveira do IFNMG - Campus Teófilo Otoni
Contação - Aprende-se ensinando nos Vales e Gerais

Ano: 2019
Autor(es)/Organizadores: Alunos do Grêmio Estudantil Campus: Teófilo Otoni
Descrição: Sarau Cultural de Primavera organizado pelos discentes do Grêmio Estudantil do IFNMG - Campus Teófilo Otoni no ano de 2019. As apresentações ocorreram na Praça Tiradentes do Município de Teófilo Otoni durante a Feira de Ciências
Contação - Aprende-se ensinando nos Vales e Gerais






www.ifnmg.edu.br facebook.com/ifnmgoficial instagram.com/ifnmg_oficial
